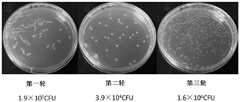

CN111153997B - Anti-CTLA-4 Nanobody and Its Application in Tumor Therapy - Google Patents
Anti-CTLA-4 Nanobody and Its Application in Tumor TherapyDownload PDFInfo
- Publication number
- CN111153997B CN111153997BCN202010048826.0ACN202010048826ACN111153997BCN 111153997 BCN111153997 BCN 111153997BCN 202010048826 ACN202010048826 ACN 202010048826ACN 111153997 BCN111153997 BCN 111153997B
- Authority
- CN
- China
- Prior art keywords
- nanobody
- cancer
- ctla
- nucleic acid
- present
- Prior art date
- Legal status (The legal status is an assumption and is not a legal conclusion. Google has not performed a legal analysis and makes no representation as to the accuracy of the status listed.)
- Active
Links
- 229940045513CTLA4 antagonistDrugs0.000titleclaimsabstractdescription60
- 206010028980NeoplasmDiseases0.000titleclaimsabstractdescription28
- 238000002560therapeutic procedureMethods0.000titledescription3
- 102000008203CTLA-4 AntigenHuman genes0.000claimsabstractdescription29
- 108010021064CTLA-4 AntigenProteins0.000claimsabstractdescription29
- 238000011282treatmentMethods0.000claimsabstractdescription13
- 125000003275alpha amino acid groupChemical group0.000claimsabstract3
- 150000007523nucleic acidsChemical class0.000claimsdescription29
- 108091028043Nucleic acid sequenceProteins0.000claimsdescription16
- 239000013604expression vectorSubstances0.000claimsdescription15
- 108020004707nucleic acidsProteins0.000claimsdescription15
- 102000039446nucleic acidsHuman genes0.000claimsdescription15
- 239000008194pharmaceutical compositionSubstances0.000claimsdescription14
- 208000035250cutaneous malignant susceptibility to 1 melanomaDiseases0.000claimsdescription6
- 239000003937drug carrierSubstances0.000claimsdescription6
- 201000001441melanomaDiseases0.000claimsdescription6
- 230000001105regulatory effectEffects0.000claimsdescription6
- 206010058467Lung neoplasm malignantDiseases0.000claimsdescription5
- 201000005202lung cancerDiseases0.000claimsdescription5
- 208000020816lung neoplasmDiseases0.000claimsdescription5
- 238000004519manufacturing processMethods0.000claimsdescription5
- 238000012258culturingMethods0.000claimsdescription4
- 206010060862Prostate cancerDiseases0.000claimsdescription3
- 208000000236Prostatic NeoplasmsDiseases0.000claimsdescription3
- 239000003623enhancerSubstances0.000claimsdescription3
- 238000002360preparation methodMethods0.000claimsdescription3
- 206010005003Bladder cancerDiseases0.000claimsdescription2
- 206010006187Breast cancerDiseases0.000claimsdescription2
- 208000026310Breast neoplasmDiseases0.000claimsdescription2
- 206010008342Cervix carcinomaDiseases0.000claimsdescription2
- 206010009944Colon cancerDiseases0.000claimsdescription2
- 208000032612Glial tumorDiseases0.000claimsdescription2
- 206010018338GliomaDiseases0.000claimsdescription2
- 208000002250Hematologic NeoplasmsDiseases0.000claimsdescription2
- 208000008839Kidney NeoplasmsDiseases0.000claimsdescription2
- 206010023825Laryngeal cancerDiseases0.000claimsdescription2
- 206010025323LymphomasDiseases0.000claimsdescription2
- 208000001894Nasopharyngeal NeoplasmsDiseases0.000claimsdescription2
- 206010061306Nasopharyngeal cancerDiseases0.000claimsdescription2
- 206010033128Ovarian cancerDiseases0.000claimsdescription2
- 206010061535Ovarian neoplasmDiseases0.000claimsdescription2
- 208000015634Rectal NeoplasmsDiseases0.000claimsdescription2
- 206010038389Renal cancerDiseases0.000claimsdescription2
- 206010041067Small cell lung cancerDiseases0.000claimsdescription2
- 208000005718Stomach NeoplasmsDiseases0.000claimsdescription2
- 208000007097Urinary Bladder NeoplasmsDiseases0.000claimsdescription2
- 208000006105Uterine Cervical NeoplasmsDiseases0.000claimsdescription2
- 201000010881cervical cancerDiseases0.000claimsdescription2
- 208000029742colonic neoplasmDiseases0.000claimsdescription2
- 239000003814drugSubstances0.000claimsdescription2
- 206010017758gastric cancerDiseases0.000claimsdescription2
- 201000010536head and neck cancerDiseases0.000claimsdescription2
- 208000014829head and neck neoplasmDiseases0.000claimsdescription2
- 201000010982kidney cancerDiseases0.000claimsdescription2
- 206010023841laryngeal neoplasmDiseases0.000claimsdescription2
- 201000007270liver cancerDiseases0.000claimsdescription2
- 208000014018liver neoplasmDiseases0.000claimsdescription2
- 208000002154non-small cell lung carcinomaDiseases0.000claimsdescription2
- 201000008968osteosarcomaDiseases0.000claimsdescription2
- 206010038038rectal cancerDiseases0.000claimsdescription2
- 201000001275rectum cancerDiseases0.000claimsdescription2
- 208000000587small cell lung carcinomaDiseases0.000claimsdescription2
- 201000011549stomach cancerDiseases0.000claimsdescription2
- 208000029729tumor suppressor gene on chromosome 11Diseases0.000claimsdescription2
- 201000005112urinary bladder cancerDiseases0.000claimsdescription2
- 208000023963corpus uteri neoplasmDiseases0.000claims1
- 230000027455bindingEffects0.000abstractdescription15
- 238000006467substitution reactionMethods0.000abstractdescription13
- 238000003745diagnosisMethods0.000abstractdescription5
- 210000004027cellAnatomy0.000description48
- 150000001413amino acidsChemical group0.000description31
- 108010003723Single-Domain AntibodiesProteins0.000description30
- 239000000243solutionSubstances0.000description30
- 239000000047productSubstances0.000description29
- 238000000034methodMethods0.000description19
- 239000000427antigenSubstances0.000description14
- 102000036639antigensHuman genes0.000description14
- 108091007433antigensProteins0.000description14
- 229940024606amino acidDrugs0.000description13
- 230000037396body weightEffects0.000description13
- UQLDLKMNUJERMK-UHFFFAOYSA-Ldi(octadecanoyloxy)leadChemical compound[Pb+2].CCCCCCCCCCCCCCCCCC([O-])=O.CCCCCCCCCCCCCCCCCC([O-])=OUQLDLKMNUJERMK-UHFFFAOYSA-L0.000description13
- 108090000623proteins and genesProteins0.000description13
- 238000004091panningMethods0.000description11
- 230000014509gene expressionEffects0.000description10
- 238000002965ELISAMethods0.000description9
- 239000006228supernatantSubstances0.000description9
- 239000002609mediumSubstances0.000description8
- 239000013598vectorSubstances0.000description8
- 230000000694effectsEffects0.000description7
- 239000000203mixtureSubstances0.000description7
- 108010047041Complementarity Determining RegionsProteins0.000description6
- 108020004414DNAProteins0.000description6
- 108091007491NSP3 Papain-like protease domainsProteins0.000description6
- PXHVJJICTQNCMI-UHFFFAOYSA-NNickelChemical compound[Ni]PXHVJJICTQNCMI-UHFFFAOYSA-N0.000description6
- 210000001744T-lymphocyteAnatomy0.000description6
- 238000006243chemical reactionMethods0.000description6
- 102000004169proteins and genesHuman genes0.000description6
- 230000001580bacterial effectEffects0.000description5
- 238000001514detection methodMethods0.000description5
- 235000013861fat-freeNutrition0.000description5
- 230000006870functionEffects0.000description5
- 239000008267milkSubstances0.000description5
- 210000004080milkAnatomy0.000description5
- 235000013336milkNutrition0.000description5
- 239000013642negative controlSubstances0.000description5
- 239000013612plasmidSubstances0.000description5
- FWMNVWWHGCHHJJ-SKKKGAJSSA-N4-amino-1-[(2r)-6-amino-2-[[(2r)-2-[[(2r)-2-[[(2r)-2-amino-3-phenylpropanoyl]amino]-3-phenylpropanoyl]amino]-4-methylpentanoyl]amino]hexanoyl]piperidine-4-carboxylic acidChemical compoundC([C@H](C(=O)N[C@H](CC(C)C)C(=O)N[C@H](CCCCN)C(=O)N1CCC(N)(CC1)C(O)=O)NC(=O)[C@H](N)CC=1C=CC=CC=1)C1=CC=CC=C1FWMNVWWHGCHHJJ-SKKKGAJSSA-N0.000description4
- QAOWNCQODCNURD-UHFFFAOYSA-NSulfuric acidChemical compoundOS(O)(=O)=OQAOWNCQODCNURD-UHFFFAOYSA-N0.000description4
- 239000003153chemical reaction reagentSubstances0.000description4
- 238000000576coating methodMethods0.000description4
- 238000001962electrophoresisMethods0.000description4
- 239000000843powderSubstances0.000description4
- 238000000746purificationMethods0.000description4
- FAPWRFPIFSIZLT-UHFFFAOYSA-MSodium chlorideChemical compound[Na+].[Cl-]FAPWRFPIFSIZLT-UHFFFAOYSA-M0.000description3
- ZMANZCXQSJIPKH-UHFFFAOYSA-NTriethylamineChemical compoundCCN(CC)CCZMANZCXQSJIPKH-UHFFFAOYSA-N0.000description3
- 210000004369bloodAnatomy0.000description3
- 239000008280bloodSubstances0.000description3
- 238000005119centrifugationMethods0.000description3
- 239000011248coating agentSubstances0.000description3
- 201000010099diseaseDiseases0.000description3
- 208000037265diseases, disorders, signs and symptomsDiseases0.000description3
- 238000009169immunotherapyMethods0.000description3
- 230000002401inhibitory effectEffects0.000description3
- 239000003446ligandSubstances0.000description3
- 230000000670limiting effectEffects0.000description3
- 239000007788liquidSubstances0.000description3
- 210000004698lymphocyteAnatomy0.000description3
- 229910052759nickelInorganic materials0.000description3
- 108090000765processed proteins & peptidesProteins0.000description3
- 230000000717retained effectEffects0.000description3
- 239000000126substanceSubstances0.000description3
- 210000004881tumor cellAnatomy0.000description3
- 239000013603viral vectorSubstances0.000description3
- GUAHPAJOXVYFON-ZETCQYMHSA-N(8S)-8-amino-7-oxononanoic acid zwitterionChemical compoundC[C@H](N)C(=O)CCCCCC(O)=OGUAHPAJOXVYFON-ZETCQYMHSA-N0.000description2
- CFKMVGJGLGKFKI-UHFFFAOYSA-N4-chloro-m-cresolChemical compoundCC1=CC(O)=CC=C1ClCFKMVGJGLGKFKI-UHFFFAOYSA-N0.000description2
- HEDRZPFGACZZDS-UHFFFAOYSA-NChloroformChemical compoundClC(Cl)ClHEDRZPFGACZZDS-UHFFFAOYSA-N0.000description2
- 241000588724Escherichia coliSpecies0.000description2
- LFQSCWFLJHTTHZ-UHFFFAOYSA-NEthanolChemical compoundCCOLFQSCWFLJHTTHZ-UHFFFAOYSA-N0.000description2
- 241000238631HexapodaSpecies0.000description2
- KFZMGEQAYNKOFK-UHFFFAOYSA-NIsopropanolChemical compoundCC(C)OKFZMGEQAYNKOFK-UHFFFAOYSA-N0.000description2
- 241000700605VirusesSpecies0.000description2
- 239000012190activatorSubstances0.000description2
- 210000004102animal cellAnatomy0.000description2
- 239000000872bufferSubstances0.000description2
- 210000004899c-terminal regionAnatomy0.000description2
- 210000000170cell membraneAnatomy0.000description2
- 230000008859changeEffects0.000description2
- 238000004587chromatography analysisMethods0.000description2
- 238000010367cloningMethods0.000description2
- -1coatingsSubstances0.000description2
- 238000002648combination therapyMethods0.000description2
- 238000004520electroporationMethods0.000description2
- 238000002474experimental methodMethods0.000description2
- 239000012634fragmentSubstances0.000description2
- 230000028993immune responseEffects0.000description2
- 230000005847immunogenicityEffects0.000description2
- 238000010253intravenous injectionMethods0.000description2
- BPHPUYQFMNQIOC-NXRLNHOXSA-Nisopropyl beta-D-thiogalactopyranosideChemical compoundCC(C)S[C@@H]1O[C@H](CO)[C@H](O)[C@H](O)[C@H]1OBPHPUYQFMNQIOC-NXRLNHOXSA-N0.000description2
- 239000007951isotonicity adjusterSubstances0.000description2
- 239000000463materialSubstances0.000description2
- 230000002018overexpressionEffects0.000description2
- 239000008188pelletSubstances0.000description2
- 239000013641positive controlSubstances0.000description2
- 239000003755preservative agentSubstances0.000description2
- 230000008569processEffects0.000description2
- 238000001742protein purificationMethods0.000description2
- 210000003289regulatory T cellAnatomy0.000description2
- 238000011160researchMethods0.000description2
- 238000012216screeningMethods0.000description2
- 238000000926separation methodMethods0.000description2
- 238000012163sequencing techniqueMethods0.000description2
- GEHJYWRUCIMESM-UHFFFAOYSA-Lsodium sulfiteChemical compound[Na+].[Na+].[O-]S([O-])=OGEHJYWRUCIMESM-UHFFFAOYSA-L0.000description2
- 239000002904solventSubstances0.000description2
- 230000009870specific bindingEffects0.000description2
- 238000013112stability testMethods0.000description2
- 239000003381stabilizerSubstances0.000description2
- 238000001356surgical procedureMethods0.000description2
- 239000000375suspending agentSubstances0.000description2
- 230000008685targetingEffects0.000description2
- 210000001519tissueAnatomy0.000description2
- QTWJRLJHJPIABL-UHFFFAOYSA-N2-methylphenol;3-methylphenol;4-methylphenolChemical compoundCC1=CC=C(O)C=C1.CC1=CC=CC(O)=C1.CC1=CC=CC=C1OQTWJRLJHJPIABL-UHFFFAOYSA-N0.000description1
- 239000013607AAV vectorSubstances0.000description1
- YYSWCHMLFJLLBJ-ZLUOBGJFSA-NAla-Ala-SerChemical compoundC[C@H](N)C(=O)N[C@@H](C)C(=O)N[C@@H](CO)C(O)=OYYSWCHMLFJLLBJ-ZLUOBGJFSA-N0.000description1
- STACJSVFHSEZJV-GHCJXIJMSA-NAla-Asn-IleChemical compound[H]N[C@@H](C)C(=O)N[C@@H](CC(N)=O)C(=O)N[C@@H]([C@@H](C)CC)C(O)=OSTACJSVFHSEZJV-GHCJXIJMSA-N0.000description1
- YSMPVONNIWLJML-FXQIFTODSA-NAla-Asp-ProChemical compoundC[C@H](N)C(=O)N[C@@H](CC(O)=O)C(=O)N1CCC[C@H]1C(O)=OYSMPVONNIWLJML-FXQIFTODSA-N0.000description1
- CZPAHAKGPDUIPJ-CIUDSAMLSA-NAla-Gln-ProChemical compoundC[C@H](N)C(=O)N[C@@H](CCC(N)=O)C(=O)N1CCC[C@H]1C(O)=OCZPAHAKGPDUIPJ-CIUDSAMLSA-N0.000description1
- KXEVYGKATAMXJJ-ACZMJKKPSA-NAla-Glu-AspChemical compoundC[C@H](N)C(=O)N[C@@H](CCC(O)=O)C(=O)N[C@@H](CC(O)=O)C(O)=OKXEVYGKATAMXJJ-ACZMJKKPSA-N0.000description1
- VGPWRRFOPXVGOH-BYPYZUCNSA-NAla-Gly-GlyChemical compoundC[C@H](N)C(=O)NCC(=O)NCC(O)=OVGPWRRFOPXVGOH-BYPYZUCNSA-N0.000description1
- XUCHENWTTBFODJ-FXQIFTODSA-NAla-Met-AlaChemical compound[H]N[C@@H](C)C(=O)N[C@@H](CCSC)C(=O)N[C@@H](C)C(O)=OXUCHENWTTBFODJ-FXQIFTODSA-N0.000description1
- FVNAUOZKIPAYNA-BPNCWPANSA-NAla-Met-TyrChemical compoundCSCC[C@H](NC(=O)[C@H](C)N)C(=O)N[C@H](C(O)=O)CC1=CC=C(O)C=C1FVNAUOZKIPAYNA-BPNCWPANSA-N0.000description1
- PEEYDECOOVQKRZ-DLOVCJGASA-NAla-Ser-PheChemical compound[H]N[C@@H](C)C(=O)N[C@@H](CO)C(=O)N[C@@H](CC1=CC=CC=C1)C(O)=OPEEYDECOOVQKRZ-DLOVCJGASA-N0.000description1
- ZXKNLCPUNZPFGY-LEWSCRJBSA-NAla-Tyr-ProChemical compoundC[C@@H](C(=O)N[C@@H](CC1=CC=C(C=C1)O)C(=O)N2CCC[C@@H]2C(=O)O)NZXKNLCPUNZPFGY-LEWSCRJBSA-N0.000description1
- 239000004475ArginineSubstances0.000description1
- CUQDCPXNZPDYFQ-ZLUOBGJFSA-NAsp-Ser-AspChemical compound[H]N[C@@H](CC(O)=O)C(=O)N[C@@H](CO)C(=O)N[C@@H](CC(O)=O)C(O)=OCUQDCPXNZPDYFQ-ZLUOBGJFSA-N0.000description1
- 108010074708B7-H1 AntigenProteins0.000description1
- 102000008096B7-H1 AntigenHuman genes0.000description1
- 241000894006BacteriaSpecies0.000description1
- 241000282832CamelidaeSpecies0.000description1
- 241000282828Camelus bactrianusSpecies0.000description1
- 241000282836Camelus dromedariusSpecies0.000description1
- 241000283707CapraSpecies0.000description1
- HJGUQJJJXQGXGJ-FXQIFTODSA-NCys-Met-SerChemical compoundCSCC[C@@H](C(=O)N[C@@H](CO)C(=O)O)NC(=O)[C@H](CS)NHJGUQJJJXQGXGJ-FXQIFTODSA-N0.000description1
- 102000053602DNAHuman genes0.000description1
- 102000012410DNA LigasesHuman genes0.000description1
- 108010061982DNA LigasesProteins0.000description1
- 239000006144Dulbecco’s modified Eagle's mediumSubstances0.000description1
- 241000196324EmbryophytaSpecies0.000description1
- 102000004533EndonucleasesHuman genes0.000description1
- 108010042407EndonucleasesProteins0.000description1
- 102000004190EnzymesHuman genes0.000description1
- 108090000790EnzymesProteins0.000description1
- 102000009109Fc receptorsHuman genes0.000description1
- 108010087819Fc receptorsProteins0.000description1
- MSHXWFKYXJTLEZ-CIUDSAMLSA-NGln-Met-AsnChemical compoundCSCC[C@@H](C(=O)N[C@@H](CC(=O)N)C(=O)O)NC(=O)[C@H](CCC(=O)N)NMSHXWFKYXJTLEZ-CIUDSAMLSA-N0.000description1
- SYZZMPFLOLSMHL-XHNCKOQMSA-NGln-Ser-ProChemical compoundC1C[C@@H](N(C1)C(=O)[C@H](CO)NC(=O)[C@H](CCC(=O)N)N)C(=O)OSYZZMPFLOLSMHL-XHNCKOQMSA-N0.000description1
- ZFBBMCKQSNJZSN-AUTRQRHGSA-NGln-Val-GlnChemical compound[H]N[C@@H](CCC(N)=O)C(=O)N[C@@H](C(C)C)C(=O)N[C@@H](CCC(N)=O)C(O)=OZFBBMCKQSNJZSN-AUTRQRHGSA-N0.000description1
- HILMIYALTUQTRC-XVKPBYJWSA-NGlu-Gly-ValChemical compound[H]N[C@@H](CCC(O)=O)C(=O)NCC(=O)N[C@@H](C(C)C)C(O)=OHILMIYALTUQTRC-XVKPBYJWSA-N0.000description1
- RGJKYNUINKGPJN-RWRJDSDZSA-NGlu-Thr-IleChemical compoundCC[C@H](C)[C@@H](C(=O)O)NC(=O)[C@H]([C@@H](C)O)NC(=O)[C@H](CCC(=O)O)NRGJKYNUINKGPJN-RWRJDSDZSA-N0.000description1
- KRRMJKMGWWXWDW-STQMWFEESA-NGly-Arg-PheChemical compoundNC(=N)NCCC[C@H](NC(=O)CN)C(=O)N[C@H](C(O)=O)CC1=CC=CC=C1KRRMJKMGWWXWDW-STQMWFEESA-N0.000description1
- SUDUYJOBLHQAMI-WHFBIAKZSA-NGly-Asp-CysChemical compoundNCC(=O)N[C@@H](CC(O)=O)C(=O)N[C@@H](CS)C(O)=OSUDUYJOBLHQAMI-WHFBIAKZSA-N0.000description1
- LCRDMSSAKLTKBU-ZDLURKLDSA-NGly-Ser-ThrChemical compoundC[C@@H](O)[C@@H](C(O)=O)NC(=O)[C@H](CO)NC(=O)CNLCRDMSSAKLTKBU-ZDLURKLDSA-N0.000description1
- CQMFNTVQVLQRLT-JHEQGTHGSA-NGly-Thr-GlnChemical compound[H]NCC(=O)N[C@@H]([C@@H](C)O)C(=O)N[C@@H](CCC(N)=O)C(O)=OCQMFNTVQVLQRLT-JHEQGTHGSA-N0.000description1
- 101001117317Homo sapiens Programmed cell death 1 ligand 1Proteins0.000description1
- 101000914514Homo sapiens T-cell-specific surface glycoprotein CD28Proteins0.000description1
- 101000914484Homo sapiens T-lymphocyte activation antigen CD80Proteins0.000description1
- 229920000663Hydroxyethyl cellulosePolymers0.000description1
- 239000004354Hydroxyethyl celluloseSubstances0.000description1
- 229920002153Hydroxypropyl cellulosePolymers0.000description1
- 102000037982Immune checkpoint proteinsHuman genes0.000description1
- 108091008036Immune checkpoint proteinsProteins0.000description1
- 108060003951ImmunoglobulinProteins0.000description1
- PMGDADKJMCOXHX-UHFFFAOYSA-NL-Arginyl-L-glutamin-acetatNatural productsNC(=N)NCCCC(N)C(=O)NC(CCC(N)=O)C(O)=OPMGDADKJMCOXHX-UHFFFAOYSA-N0.000description1
- ODKSFYDXXFIFQN-BYPYZUCNSA-PL-argininium(2+)Chemical compoundNC(=[NH2+])NCCC[C@H]([NH3+])C(O)=OODKSFYDXXFIFQN-BYPYZUCNSA-P0.000description1
- HNDVDQJCIGZPNO-YFKPBYRVSA-NL-histidineChemical compoundOC(=O)[C@@H](N)CC1=CN=CN1HNDVDQJCIGZPNO-YFKPBYRVSA-N0.000description1
- AGPKZVBTJJNPAG-WHFBIAKZSA-NL-isoleucineChemical compoundCC[C@H](C)[C@H](N)C(O)=OAGPKZVBTJJNPAG-WHFBIAKZSA-N0.000description1
- ROHFNLRQFUQHCH-YFKPBYRVSA-NL-leucineChemical compoundCC(C)C[C@H](N)C(O)=OROHFNLRQFUQHCH-YFKPBYRVSA-N0.000description1
- KDXKERNSBIXSRK-YFKPBYRVSA-NL-lysineChemical compoundNCCCC[C@H](N)C(O)=OKDXKERNSBIXSRK-YFKPBYRVSA-N0.000description1
- FFEARJCKVFRZRR-BYPYZUCNSA-NL-methionineChemical compoundCSCC[C@H](N)C(O)=OFFEARJCKVFRZRR-BYPYZUCNSA-N0.000description1
- KZSNJWFQEVHDMF-BYPYZUCNSA-NL-valineChemical compoundCC(C)[C@H](N)C(O)=OKZSNJWFQEVHDMF-BYPYZUCNSA-N0.000description1
- ZTLGVASZOIKNIX-DCAQKATOSA-NLeu-Gln-GluChemical compoundCC(C)C[C@@H](C(=O)N[C@@H](CCC(=O)N)C(=O)N[C@@H](CCC(=O)O)C(=O)O)NZTLGVASZOIKNIX-DCAQKATOSA-N0.000description1
- KIZIOFNVSOSKJI-CIUDSAMLSA-NLeu-Ser-CysChemical compoundCC(C)C[C@@H](C(=O)N[C@@H](CO)C(=O)N[C@@H](CS)C(=O)O)NKIZIOFNVSOSKJI-CIUDSAMLSA-N0.000description1
- JGKHAFUAPZCCDU-BZSNNMDCSA-NLeu-Tyr-LeuChemical compoundCC(C)C[C@H]([NH3+])C(=O)N[C@H](C(=O)N[C@@H](CC(C)C)C([O-])=O)CC1=CC=C(O)C=C1JGKHAFUAPZCCDU-BZSNNMDCSA-N0.000description1
- 240000007472Leucaena leucocephalaSpecies0.000description1
- 235000010643Leucaena leucocephalaNutrition0.000description1
- ROHFNLRQFUQHCH-UHFFFAOYSA-NLeucineNatural productsCC(C)CC(N)C(O)=OROHFNLRQFUQHCH-UHFFFAOYSA-N0.000description1
- RVOMPSJXSRPFJT-DCAQKATOSA-NLys-Ala-ArgChemical compound[H]N[C@@H](CCCCN)C(=O)N[C@@H](C)C(=O)N[C@@H](CCCNC(N)=N)C(O)=ORVOMPSJXSRPFJT-DCAQKATOSA-N0.000description1
- QUCDKEKDPYISNX-HJGDQZAQSA-NLys-Asn-ThrChemical compound[H]N[C@@H](CCCCN)C(=O)N[C@@H](CC(N)=O)C(=O)N[C@@H]([C@@H](C)O)C(O)=OQUCDKEKDPYISNX-HJGDQZAQSA-N0.000description1
- KPJJOZUXFOLGMQ-CIUDSAMLSA-NLys-Asp-AsnChemical compoundC(CCN)C[C@@H](C(=O)N[C@@H](CC(=O)O)C(=O)N[C@@H](CC(=O)N)C(=O)O)NKPJJOZUXFOLGMQ-CIUDSAMLSA-N0.000description1
- KDXKERNSBIXSRK-UHFFFAOYSA-NLysineNatural productsNCCCCC(N)C(O)=OKDXKERNSBIXSRK-UHFFFAOYSA-N0.000description1
- 239000004472LysineSubstances0.000description1
- 238000009004PCR KitMethods0.000description1
- 239000008118PEG 6000Substances0.000description1
- 240000000220Panda oleosaSpecies0.000description1
- 235000016496Panda oleosaNutrition0.000description1
- 229920002584Polyethylene Glycol 6000Polymers0.000description1
- DEDANIDYQAPTFI-IHRRRGAJSA-NPro-Asp-TyrChemical compound[H]N1CCC[C@H]1C(=O)N[C@@H](CC(O)=O)C(=O)N[C@@H](CC1=CC=C(O)C=C1)C(O)=ODEDANIDYQAPTFI-IHRRRGAJSA-N0.000description1
- 102100024216Programmed cell death 1 ligand 1Human genes0.000description1
- 240000004808Saccharomyces cerevisiaeSpecies0.000description1
- ZUGXSSFMTXKHJS-ZLUOBGJFSA-NSer-Ala-AlaChemical compound[H]N[C@@H](CO)C(=O)N[C@@H](C)C(=O)N[C@@H](C)C(O)=OZUGXSSFMTXKHJS-ZLUOBGJFSA-N0.000description1
- YMTLKLXDFCSCNX-BYPYZUCNSA-NSer-Gly-GlyChemical compoundOC[C@H](N)C(=O)NCC(=O)NCC(O)=OYMTLKLXDFCSCNX-BYPYZUCNSA-N0.000description1
- UIGMAMGZOJVTDN-WHFBIAKZSA-NSer-Gly-SerChemical compoundOC[C@H](N)C(=O)NCC(=O)N[C@@H](CO)C(O)=OUIGMAMGZOJVTDN-WHFBIAKZSA-N0.000description1
- QYSFWUIXDFJUDW-DCAQKATOSA-NSer-Leu-ArgChemical compound[H]N[C@@H](CO)C(=O)N[C@@H](CC(C)C)C(=O)N[C@@H](CCCNC(N)=N)C(O)=OQYSFWUIXDFJUDW-DCAQKATOSA-N0.000description1
- UBRMZSHOOIVJPW-SRVKXCTJSA-NSer-Leu-LysChemical compoundOC[C@H](N)C(=O)N[C@@H](CC(C)C)C(=O)N[C@@H](CCCCN)C(O)=OUBRMZSHOOIVJPW-SRVKXCTJSA-N0.000description1
- XGQKSRGHEZNWIS-IHRRRGAJSA-NSer-Pro-TyrChemical compoundN[C@@H](CO)C(=O)N1CCC[C@H]1C(=O)N[C@@H](Cc1ccc(O)cc1)C(O)=OXGQKSRGHEZNWIS-IHRRRGAJSA-N0.000description1
- LLSLRQOEAFCZLW-NRPADANISA-NSer-Val-GlnChemical compound[H]N[C@@H](CO)C(=O)N[C@@H](C(C)C)C(=O)N[C@@H](CCC(N)=O)C(O)=OLLSLRQOEAFCZLW-NRPADANISA-N0.000description1
- LGIMRDKGABDMBN-DCAQKATOSA-NSer-Val-LysChemical compoundCC(C)[C@@H](C(=O)N[C@@H](CCCCN)C(=O)O)NC(=O)[C@H](CO)NLGIMRDKGABDMBN-DCAQKATOSA-N0.000description1
- 230000017274T cell anergyEffects0.000description1
- 102100027213T-cell-specific surface glycoprotein CD28Human genes0.000description1
- 102100027222T-lymphocyte activation antigen CD80Human genes0.000description1
- FQPDRTDDEZXCEC-SVSWQMSJSA-NThr-Ile-SerChemical compound[H]N[C@@H]([C@@H](C)O)C(=O)N[C@@H]([C@@H](C)CC)C(=O)N[C@@H](CO)C(O)=OFQPDRTDDEZXCEC-SVSWQMSJSA-N0.000description1
- MNYNCKZAEIAONY-XGEHTFHBSA-NThr-Val-SerChemical compoundC[C@@H](O)[C@H](N)C(=O)N[C@@H](C(C)C)C(=O)N[C@@H](CO)C(O)=OMNYNCKZAEIAONY-XGEHTFHBSA-N0.000description1
- SVGAWGVHFIYAEE-JSGCOSHPSA-NTrp-Gly-GlnChemical compoundC1=CC=C2C(C[C@H](N)C(=O)NCC(=O)N[C@@H](CCC(N)=O)C(O)=O)=CNC2=C1SVGAWGVHFIYAEE-JSGCOSHPSA-N0.000description1
- SLOYNOMYOAOUCX-BVSLBCMMSA-NTrp-Phe-ArgChemical compound[H]N[C@@H](CC1=CNC2=C1C=CC=C2)C(=O)N[C@@H](CC1=CC=CC=C1)C(=O)N[C@@H](CCCNC(N)=N)C(O)=OSLOYNOMYOAOUCX-BVSLBCMMSA-N0.000description1
- GEGYPBOPIGNZIF-CWRNSKLLSA-NTrp-Ser-ProChemical compoundC1C[C@@H](N(C1)C(=O)[C@H](CO)NC(=O)[C@H](CC2=CNC3=CC=CC=C32)N)C(=O)OGEGYPBOPIGNZIF-CWRNSKLLSA-N0.000description1
- 102000004142TrypsinHuman genes0.000description1
- 108090000631TrypsinProteins0.000description1
- 102100022153Tumor necrosis factor receptor superfamily member 4Human genes0.000description1
- 101710165473Tumor necrosis factor receptor superfamily member 4Proteins0.000description1
- BURPTJBFWIOHEY-UWJYBYFXSA-NTyr-Ala-AspChemical compoundOC(=O)C[C@@H](C(O)=O)NC(=O)[C@H](C)NC(=O)[C@@H](N)CC1=CC=C(O)C=C1BURPTJBFWIOHEY-UWJYBYFXSA-N0.000description1
- DYEGCOJHFNJBKB-UFYCRDLUSA-NTyr-Arg-TyrChemical compoundC([C@H](N)C(=O)N[C@@H](CCCN=C(N)N)C(=O)N[C@@H](CC=1C=CC(O)=CC=1)C(O)=O)C1=CC=C(O)C=C1DYEGCOJHFNJBKB-UFYCRDLUSA-N0.000description1
- UABYBEBXFFNCIR-YDHLFZDLSA-NTyr-Asp-ValChemical compound[H]N[C@@H](CC1=CC=C(O)C=C1)C(=O)N[C@@H](CC(O)=O)C(=O)N[C@@H](C(C)C)C(O)=OUABYBEBXFFNCIR-YDHLFZDLSA-N0.000description1
- SMLCYZYQFRTLCO-UWJYBYFXSA-NTyr-Cys-AlaChemical compound[H]N[C@@H](CC1=CC=C(O)C=C1)C(=O)N[C@@H](CS)C(=O)N[C@@H](C)C(O)=OSMLCYZYQFRTLCO-UWJYBYFXSA-N0.000description1
- KZSNJWFQEVHDMF-UHFFFAOYSA-NValineNatural productsCC(C)C(N)C(O)=OKZSNJWFQEVHDMF-UHFFFAOYSA-N0.000description1
- 238000002835absorbanceMethods0.000description1
- 239000003070absorption delaying agentSubstances0.000description1
- DPXJVFZANSGRMM-UHFFFAOYSA-Nacetic acid;2,3,4,5,6-pentahydroxyhexanal;sodiumChemical compound[Na].CC(O)=O.OCC(O)C(O)C(O)C(O)C=ODPXJVFZANSGRMM-UHFFFAOYSA-N0.000description1
- 238000001042affinity chromatographyMethods0.000description1
- 108010008685alanyl-glutamyl-aspartic acidProteins0.000description1
- 108010076324alanyl-glycyl-glycineProteins0.000description1
- 108010086434alanyl-seryl-glycineProteins0.000description1
- 108010044940alanylglutamineProteins0.000description1
- 229960000723ampicillinDrugs0.000description1
- AVKUERGKIZMTKX-NJBDSQKTSA-NampicillinChemical compoundC1([C@@H](N)C(=O)N[C@H]2[C@H]3SC([C@@H](N3C2=O)C(O)=O)(C)C)=CC=CC=C1AVKUERGKIZMTKX-NJBDSQKTSA-N0.000description1
- 230000003698anagen phaseEffects0.000description1
- 238000004458analytical methodMethods0.000description1
- 239000003242anti bacterial agentSubstances0.000description1
- 230000000844anti-bacterial effectEffects0.000description1
- 229940121375antifungal agentDrugs0.000description1
- 239000003429antifungal agentSubstances0.000description1
- 230000000890antigenic effectEffects0.000description1
- 239000002246antineoplastic agentSubstances0.000description1
- 229940041181antineoplastic drugDrugs0.000description1
- 239000008346aqueous phaseSubstances0.000description1
- ODKSFYDXXFIFQN-UHFFFAOYSA-NarginineNatural productsOC(=O)C(N)CCCNC(N)=NODKSFYDXXFIFQN-UHFFFAOYSA-N0.000description1
- 108010013835arginine glutamateProteins0.000description1
- 108010008355arginyl-glutamineProteins0.000description1
- 210000004507artificial chromosomeAnatomy0.000description1
- 125000003118aryl groupChemical group0.000description1
- 108010047857aspartylglycineProteins0.000description1
- 230000001363autoimmuneEffects0.000description1
- 230000008901benefitEffects0.000description1
- 230000004071biological effectEffects0.000description1
- 229960000074biopharmaceuticalDrugs0.000description1
- 238000010805cDNA synthesis kitMethods0.000description1
- 201000011510cancerDiseases0.000description1
- 239000001768carboxy methyl celluloseSubstances0.000description1
- 239000006285cell suspensionSubstances0.000description1
- 239000003795chemical substances by applicationSubstances0.000description1
- 238000002512chemotherapyMethods0.000description1
- 210000004978chinese hamster ovary cellAnatomy0.000description1
- 229960002242chlorocresolDrugs0.000description1
- 239000012916chromogenic reagentSubstances0.000description1
- 238000003759clinical diagnosisMethods0.000description1
- 230000000295complement effectEffects0.000description1
- 150000001875compoundsChemical class0.000description1
- NKLPQNGYXWVELD-UHFFFAOYSA-Mcoomassie brilliant blueChemical compound[Na+].C1=CC(OCC)=CC=C1NC1=CC=C(C(=C2C=CC(C=C2)=[N+](CC)CC=2C=C(C=CC=2)S([O-])(=O)=O)C=2C=CC(=CC=2)N(CC)CC=2C=C(C=CC=2)S([O-])(=O)=O)C=C1NKLPQNGYXWVELD-UHFFFAOYSA-M0.000description1
- 230000000139costimulatory effectEffects0.000description1
- 229930003836cresolNatural products0.000description1
- 229940013361cresolDrugs0.000description1
- 108010069495cysteinyltyrosineProteins0.000description1
- 230000007423decreaseEffects0.000description1
- 238000010586diagramMethods0.000description1
- 238000000502dialysisMethods0.000description1
- MTHSVFCYNBDYFN-UHFFFAOYSA-Ndiethylene glycolChemical compoundOCCOCCOMTHSVFCYNBDYFN-UHFFFAOYSA-N0.000description1
- 230000004069differentiationEffects0.000description1
- 230000029087digestionEffects0.000description1
- 239000003085diluting agentSubstances0.000description1
- 239000002612dispersion mediumSubstances0.000description1
- 239000002552dosage formSubstances0.000description1
- 230000002255enzymatic effectEffects0.000description1
- BEFDCLMNVWHSGT-UHFFFAOYSA-NethenylcyclopentaneChemical compoundC=CC1CCCC1BEFDCLMNVWHSGT-UHFFFAOYSA-N0.000description1
- 210000003527eukaryotic cellAnatomy0.000description1
- MHMNJMPURVTYEJ-UHFFFAOYSA-Nfluorescein-5-isothiocyanateChemical compoundO1C(=O)C2=CC(N=C=S)=CC=C2C21C1=CC=C(O)C=C1OC1=CC(O)=CC=C21MHMNJMPURVTYEJ-UHFFFAOYSA-N0.000description1
- 238000001502gel electrophoresisMethods0.000description1
- 238000012239gene modificationMethods0.000description1
- 230000002068genetic effectEffects0.000description1
- 238000010353genetic engineeringMethods0.000description1
- 230000005017genetic modificationEffects0.000description1
- 235000013617genetically modified foodNutrition0.000description1
- 108010078144glutaminyl-glycineProteins0.000description1
- 108010067216glycyl-glycyl-glycineProteins0.000description1
- XKUKSGPZAADMRA-UHFFFAOYSA-Nglycyl-glycyl-glycineNatural productsNCC(=O)NCC(=O)NCC(O)=OXKUKSGPZAADMRA-UHFFFAOYSA-N0.000description1
- 230000012010growthEffects0.000description1
- HNDVDQJCIGZPNO-UHFFFAOYSA-NhistidineNatural productsOC(=O)C(N)CC1=CN=CN1HNDVDQJCIGZPNO-UHFFFAOYSA-N0.000description1
- 229910052739hydrogenInorganic materials0.000description1
- 239000001257hydrogenSubstances0.000description1
- 230000002209hydrophobic effectEffects0.000description1
- 235000019447hydroxyethyl celluloseNutrition0.000description1
- 229910052588hydroxylapatiteInorganic materials0.000description1
- 239000001863hydroxypropyl celluloseSubstances0.000description1
- 235000010977hydroxypropyl celluloseNutrition0.000description1
- 210000000987immune systemAnatomy0.000description1
- 238000002649immunizationMethods0.000description1
- 230000003053immunizationEffects0.000description1
- 102000018358immunoglobulinHuman genes0.000description1
- 230000006872improvementEffects0.000description1
- 239000012535impuritySubstances0.000description1
- 238000001727in vivoMethods0.000description1
- 239000004615ingredientSubstances0.000description1
- 229960005386ipilimumabDrugs0.000description1
- AGPKZVBTJJNPAG-UHFFFAOYSA-NisoleucineNatural productsCCC(C)C(N)C(O)=OAGPKZVBTJJNPAG-UHFFFAOYSA-N0.000description1
- 229960000310isoleucineDrugs0.000description1
- 229930027917kanamycinNatural products0.000description1
- 229960000318kanamycinDrugs0.000description1
- SBUJHOSQTJFQJX-NOAMYHISSA-NkanamycinChemical compoundO[C@@H]1[C@@H](O)[C@H](O)[C@@H](CN)O[C@@H]1O[C@H]1[C@H](O)[C@@H](O[C@@H]2[C@@H]([C@@H](N)[C@H](O)[C@@H](CO)O2)O)[C@H](N)C[C@@H]1NSBUJHOSQTJFQJX-NOAMYHISSA-N0.000description1
- 229930182823kanamycin ANatural products0.000description1
- 230000002147killing effectEffects0.000description1
- 210000000265leukocyteAnatomy0.000description1
- 210000004962mammalian cellAnatomy0.000description1
- 230000001404mediated effectEffects0.000description1
- 229930182817methionineNatural products0.000description1
- 229920000609methyl cellulosePolymers0.000description1
- 239000001923methylcelluloseSubstances0.000description1
- 235000010981methylcelluloseNutrition0.000description1
- 244000005700microbiomeSpecies0.000description1
- 230000004048modificationEffects0.000description1
- 238000012986modificationMethods0.000description1
- 230000017095negative regulation of cell growthEffects0.000description1
- 230000012177negative regulation of immune responseEffects0.000description1
- 239000002773nucleotideSubstances0.000description1
- 125000003729nucleotide groupChemical group0.000description1
- 230000003204osmotic effectEffects0.000description1
- 238000007911parenteral administrationMethods0.000description1
- 230000035515penetrationEffects0.000description1
- XYJRXVWERLGGKC-UHFFFAOYSA-Dpentacalcium;hydroxide;triphosphateChemical compound[OH-].[Ca+2].[Ca+2].[Ca+2].[Ca+2].[Ca+2].[O-]P([O-])([O-])=O.[O-]P([O-])([O-])=O.[O-]P([O-])([O-])=OXYJRXVWERLGGKC-UHFFFAOYSA-D0.000description1
- 210000005259peripheral bloodAnatomy0.000description1
- 239000011886peripheral bloodSubstances0.000description1
- 230000035699permeabilityEffects0.000description1
- 239000013600plasmid vectorSubstances0.000description1
- 229920001184polypeptidePolymers0.000description1
- 239000002244precipitateSubstances0.000description1
- 238000004321preservationMethods0.000description1
- 102000004196processed proteins & peptidesHuman genes0.000description1
- 210000001236prokaryotic cellAnatomy0.000description1
- 230000001737promoting effectEffects0.000description1
- 238000011127radiochemotherapyMethods0.000description1
- 238000001959radiotherapyMethods0.000description1
- 230000010076replicationEffects0.000description1
- 238000012827research and developmentMethods0.000description1
- 230000002441reversible effectEffects0.000description1
- 230000028327secretionEffects0.000description1
- 238000002864sequence alignmentMethods0.000description1
- 108010069117seryl-lysyl-aspartic acidProteins0.000description1
- 239000002453shampooSubstances0.000description1
- 229940126586small molecule drugDrugs0.000description1
- 150000003384small moleculesChemical class0.000description1
- ZLVSYODPTJZFMK-UHFFFAOYSA-Msodium 4-hydroxybenzoateChemical compound[Na+].OC1=CC=C(C([O-])=O)C=C1ZLVSYODPTJZFMK-UHFFFAOYSA-M0.000description1
- 235000019812sodium carboxymethyl celluloseNutrition0.000description1
- 229920001027sodium carboxymethylcellulosePolymers0.000description1
- 239000011780sodium chlorideSubstances0.000description1
- HRZFUMHJMZEROT-UHFFFAOYSA-Lsodium disulfiteChemical compound[Na+].[Na+].[O-]S(=O)S([O-])(=O)=OHRZFUMHJMZEROT-UHFFFAOYSA-L0.000description1
- 229940001584sodium metabisulfiteDrugs0.000description1
- 235000010262sodium metabisulphiteNutrition0.000description1
- 235000010265sodium sulphiteNutrition0.000description1
- 235000010199sorbic acidNutrition0.000description1
- 239000004334sorbic acidSubstances0.000description1
- 229940075582sorbic acidDrugs0.000description1
- 238000011895specific detectionMethods0.000description1
- 238000003153stable transfectionMethods0.000description1
- 230000000638stimulationEffects0.000description1
- 230000004083survival effectEffects0.000description1
- 239000000725suspensionSubstances0.000description1
- 208000024891symptomDiseases0.000description1
- 230000002195synergetic effectEffects0.000description1
- 230000001225therapeutic effectEffects0.000description1
- 238000013518transcriptionMethods0.000description1
- 230000035897transcriptionEffects0.000description1
- 238000001890transfectionMethods0.000description1
- 230000009466transformationEffects0.000description1
- 230000001131transforming effectEffects0.000description1
- 230000001052transient effectEffects0.000description1
- 238000003146transient transfectionMethods0.000description1
- 238000013519translationMethods0.000description1
- 230000001296transplacental effectEffects0.000description1
- 239000012588trypsinSubstances0.000description1
- 230000004614tumor growthEffects0.000description1
- 208000025421tumor of uterusDiseases0.000description1
- 108010003137tyrosyltyrosineProteins0.000description1
- 241000701161unidentified adenovirusSpecies0.000description1
- 241000701447unidentified baculovirusSpecies0.000description1
- 241001529453unidentified herpesvirusSpecies0.000description1
- 241001430294unidentified retrovirusSpecies0.000description1
- 206010046766uterine cancerDiseases0.000description1
- 239000004474valineSubstances0.000description1
- 210000003501vero cellAnatomy0.000description1
- 238000005406washingMethods0.000description1
- XLYOFNOQVPJJNP-UHFFFAOYSA-NwaterSubstancesOXLYOFNOQVPJJNP-UHFFFAOYSA-N0.000description1
- 230000003442weekly effectEffects0.000description1
- 210000005253yeast cellAnatomy0.000description1
Images
Classifications
- C—CHEMISTRY; METALLURGY
- C07—ORGANIC CHEMISTRY
- C07K—PEPTIDES
- C07K16/00—Immunoglobulins [IGs], e.g. monoclonal or polyclonal antibodies
- C07K16/18—Immunoglobulins [IGs], e.g. monoclonal or polyclonal antibodies against material from animals or humans
- C07K16/28—Immunoglobulins [IGs], e.g. monoclonal or polyclonal antibodies against material from animals or humans against receptors, cell surface antigens or cell surface determinants
- C07K16/2803—Immunoglobulins [IGs], e.g. monoclonal or polyclonal antibodies against material from animals or humans against receptors, cell surface antigens or cell surface determinants against the immunoglobulin superfamily
- C07K16/2818—Immunoglobulins [IGs], e.g. monoclonal or polyclonal antibodies against material from animals or humans against receptors, cell surface antigens or cell surface determinants against the immunoglobulin superfamily against CD28 or CD152
- A—HUMAN NECESSITIES
- A61—MEDICAL OR VETERINARY SCIENCE; HYGIENE
- A61P—SPECIFIC THERAPEUTIC ACTIVITY OF CHEMICAL COMPOUNDS OR MEDICINAL PREPARATIONS
- A61P35/00—Antineoplastic agents
- C—CHEMISTRY; METALLURGY
- C12—BIOCHEMISTRY; BEER; SPIRITS; WINE; VINEGAR; MICROBIOLOGY; ENZYMOLOGY; MUTATION OR GENETIC ENGINEERING
- C12N—MICROORGANISMS OR ENZYMES; COMPOSITIONS THEREOF; PROPAGATING, PRESERVING, OR MAINTAINING MICROORGANISMS; MUTATION OR GENETIC ENGINEERING; CULTURE MEDIA
- C12N15/00—Mutation or genetic engineering; DNA or RNA concerning genetic engineering, vectors, e.g. plasmids, or their isolation, preparation or purification; Use of hosts therefor
- C12N15/09—Recombinant DNA-technology
- C12N15/63—Introduction of foreign genetic material using vectors; Vectors; Use of hosts therefor; Regulation of expression
- C12N15/79—Vectors or expression systems specially adapted for eukaryotic hosts
- C12N15/85—Vectors or expression systems specially adapted for eukaryotic hosts for animal cells
- C12N15/86—Viral vectors
- C—CHEMISTRY; METALLURGY
- C12—BIOCHEMISTRY; BEER; SPIRITS; WINE; VINEGAR; MICROBIOLOGY; ENZYMOLOGY; MUTATION OR GENETIC ENGINEERING
- C12N—MICROORGANISMS OR ENZYMES; COMPOSITIONS THEREOF; PROPAGATING, PRESERVING, OR MAINTAINING MICROORGANISMS; MUTATION OR GENETIC ENGINEERING; CULTURE MEDIA
- C12N5/00—Undifferentiated human, animal or plant cells, e.g. cell lines; Tissues; Cultivation or maintenance thereof; Culture media therefor
- C12N5/06—Animal cells or tissues; Human cells or tissues
- C12N5/0602—Vertebrate cells
- C12N5/0634—Cells from the blood or the immune system
- C12N5/0636—T lymphocytes
- G—PHYSICS
- G01—MEASURING; TESTING
- G01N—INVESTIGATING OR ANALYSING MATERIALS BY DETERMINING THEIR CHEMICAL OR PHYSICAL PROPERTIES
- G01N33/00—Investigating or analysing materials by specific methods not covered by groups G01N1/00 - G01N31/00
- G01N33/48—Biological material, e.g. blood, urine; Haemocytometers
- G01N33/50—Chemical analysis of biological material, e.g. blood, urine; Testing involving biospecific ligand binding methods; Immunological testing
- G01N33/68—Chemical analysis of biological material, e.g. blood, urine; Testing involving biospecific ligand binding methods; Immunological testing involving proteins, peptides or amino acids
- A—HUMAN NECESSITIES
- A61—MEDICAL OR VETERINARY SCIENCE; HYGIENE
- A61K—PREPARATIONS FOR MEDICAL, DENTAL OR TOILETRY PURPOSES
- A61K39/00—Medicinal preparations containing antigens or antibodies
- A61K2039/505—Medicinal preparations containing antigens or antibodies comprising antibodies
- C—CHEMISTRY; METALLURGY
- C07—ORGANIC CHEMISTRY
- C07K—PEPTIDES
- C07K2317/00—Immunoglobulins specific features
- C07K2317/50—Immunoglobulins specific features characterized by immunoglobulin fragments
- C07K2317/56—Immunoglobulins specific features characterized by immunoglobulin fragments variable (Fv) region, i.e. VH and/or VL
- C07K2317/569—Single domain, e.g. dAb, sdAb, VHH, VNAR or nanobody®
- C—CHEMISTRY; METALLURGY
- C12—BIOCHEMISTRY; BEER; SPIRITS; WINE; VINEGAR; MICROBIOLOGY; ENZYMOLOGY; MUTATION OR GENETIC ENGINEERING
- C12N—MICROORGANISMS OR ENZYMES; COMPOSITIONS THEREOF; PROPAGATING, PRESERVING, OR MAINTAINING MICROORGANISMS; MUTATION OR GENETIC ENGINEERING; CULTURE MEDIA
- C12N2510/00—Genetically modified cells
- C—CHEMISTRY; METALLURGY
- C12—BIOCHEMISTRY; BEER; SPIRITS; WINE; VINEGAR; MICROBIOLOGY; ENZYMOLOGY; MUTATION OR GENETIC ENGINEERING
- C12N—MICROORGANISMS OR ENZYMES; COMPOSITIONS THEREOF; PROPAGATING, PRESERVING, OR MAINTAINING MICROORGANISMS; MUTATION OR GENETIC ENGINEERING; CULTURE MEDIA
- C12N2710/00—MICROORGANISMS OR ENZYMES; COMPOSITIONS THEREOF; PROPAGATING, PRESERVING, OR MAINTAINING MICROORGANISMS; MUTATION OR GENETIC ENGINEERING; CULTURE MEDIA dsDNA viruses
- C12N2710/00011—Details
- C12N2710/14011—Baculoviridae
- C12N2710/14041—Use of virus, viral particle or viral elements as a vector
- C12N2710/14043—Use of virus, viral particle or viral elements as a vector viral genome or elements thereof as genetic vectore
- G—PHYSICS
- G01—MEASURING; TESTING
- G01N—INVESTIGATING OR ANALYSING MATERIALS BY DETERMINING THEIR CHEMICAL OR PHYSICAL PROPERTIES
- G01N2333/00—Assays involving biological materials from specific organisms or of a specific nature
- G01N2333/435—Assays involving biological materials from specific organisms or of a specific nature from animals; from humans
- G01N2333/705—Assays involving receptors, cell surface antigens or cell surface determinants
- G01N2333/70503—Immunoglobulin superfamily, e.g. VCAMs, PECAM, LFA-3
- G01N2333/70521—CD28, CD152
Landscapes
- Health & Medical Sciences (AREA)
- Life Sciences & Earth Sciences (AREA)
- Chemical & Material Sciences (AREA)
- Engineering & Computer Science (AREA)
- Immunology (AREA)
- Biomedical Technology (AREA)
- Organic Chemistry (AREA)
- Genetics & Genomics (AREA)
- Biotechnology (AREA)
- General Health & Medical Sciences (AREA)
- Molecular Biology (AREA)
- Bioinformatics & Cheminformatics (AREA)
- Zoology (AREA)
- Wood Science & Technology (AREA)
- Biochemistry (AREA)
- Medicinal Chemistry (AREA)
- General Engineering & Computer Science (AREA)
- Microbiology (AREA)
- Hematology (AREA)
- Cell Biology (AREA)
- Urology & Nephrology (AREA)
- Biophysics (AREA)
- Physics & Mathematics (AREA)
- Proteomics, Peptides & Aminoacids (AREA)
- Chemical Kinetics & Catalysis (AREA)
- Plant Pathology (AREA)
- Public Health (AREA)
- Animal Behavior & Ethology (AREA)
- Pharmacology & Pharmacy (AREA)
- Virology (AREA)
- Nuclear Medicine, Radiotherapy & Molecular Imaging (AREA)
- Veterinary Medicine (AREA)
- General Chemical & Material Sciences (AREA)
- Food Science & Technology (AREA)
- Analytical Chemistry (AREA)
- General Physics & Mathematics (AREA)
- Pathology (AREA)
- Peptides Or Proteins (AREA)
- Micro-Organisms Or Cultivation Processes Thereof (AREA)
Abstract
Description
Translated fromChinese技术领域technical field
本发明涉及医药生物学和生物制药技术领域,具体涉及一种抗CTLA-4纳米抗体及其应用。The invention relates to the technical fields of medical biology and biopharmaceuticals, in particular to an anti-CTLA-4 nanobody and application thereof.
背景技术Background technique
免疫检查点(immune checkpoint)在机体的特异性免疫过程中,主要调节T细胞介导的免疫反应。机体受到肿瘤侵袭时,肿瘤细胞通过异常上调抑制性共刺激分子及其配体表达,抑制T细胞发挥功能,有利于肿瘤细胞的生长和逃逸。细胞毒T淋巴细胞相关抗原4(cytotoxic T lymphocyte-associated antigen-4,CTLA-4)是一种白细胞分化抗原,是T细胞上的一种跨膜抑制性共受体。CTLA-4与T细胞刺激协同B7家族分子结合后诱导T细胞无反应性,参与免疫反应的负调节。而且CTLA-4也在调节性T细胞(Tregs)中发现并有助于它们的抑制功能。CTLA-4的配体在许多实体瘤中存在高度表达的水平。当这些配体与T细胞上的CTLA-4结合后下调T细胞的免疫应答,从而使得肿瘤细胞逃逸免疫系统的识别和杀伤作用。因此CTLA-4是肿瘤免疫治疗的重要靶点。目前多使用抗CTLA-4抗体用于肿瘤治疗,这些抗体都是传统的抗体分子,分子量大,需要在动物细胞中进行表达生产。因而具有生产成本高,在体内可能会导致免疫原性等缺点。The immune checkpoint mainly regulates the immune response mediated by T cells in the specific immune process of the body. When the body is invaded by tumors, tumor cells abnormally up-regulate the expression of inhibitory costimulatory molecules and their ligands, inhibiting the function of T cells, which is conducive to the growth and escape of tumor cells. Cytotoxic T lymphocyte-associated antigen-4 (CTLA-4) is a leukocyte differentiation antigen and a transmembrane inhibitory co-receptor on T cells. CTLA-4 induces T cell anergy after binding to T cell stimulation synergistic B7 family molecules, and participates in the negative regulation of immune response. Furthermore, CTLA-4 is also found in regulatory T cells (Tregs) and contributes to their suppressive function. The ligand for CTLA-4 is highly expressed in many solid tumors. When these ligands bind to CTLA-4 on T cells, they down-regulate the immune response of T cells, thereby allowing tumor cells to escape the recognition and killing effects of the immune system. Therefore, CTLA-4 is an important target for tumor immunotherapy. At present, anti-CTLA-4 antibodies are mostly used for tumor treatment. These antibodies are traditional antibody molecules with large molecular weights, which need to be expressed and produced in animal cells. Therefore, it has the disadvantages of high production cost and possible immunogenicity in vivo.
小分子纳米抗体由于具有分子质量小,体积小,无Fc段等性质,使它们在很多方面的表现优于传统抗体,免疫原性低,它们不易产生自身免疫反应;有很强的组织渗透性;易于结合隐蔽的抗原表位;可用微生物进行生产,且生产成本低等优势。Due to their small molecular weight, small size, and no Fc segment, small molecule nanobodies outperform traditional antibodies in many aspects, with low immunogenicity, and they are not prone to autoimmune reactions; they have strong tissue permeability ; Easy to combine with hidden antigenic epitopes; It can be produced by microorganisms and has the advantages of low production cost.
然后抗CTLA-4纳米抗体还需要进一步改进。Then the anti-CTLA-4 nanobody needs further improvement.
发明内容SUMMARY OF THE INVENTION
本发明旨在至少在一定程度上解决相关技术中的技术问题之一。为此,本发明的一个目的在于提出一种抗CTL-4纳米抗体及其应用。The present invention aims to solve one of the technical problems in the related art at least to a certain extent. Therefore, an object of the present invention is to propose an anti-CTL-4 nanobody and its application.
我们抽取骆驼外周血构建噬菌体文库,从中筛选获得抗CTLA-4纳米抗体,并将其在大肠杆菌和酵母中进行表达。所获得的抗CTLA-4纳米抗体分子量小,特异性强,与CTLA-4胞外段的结合能力强,因而可以用于CTLA-4高表达的肿瘤的诊断和治疗。We extracted camel peripheral blood to construct a phage library, obtained anti-CTLA-4 nanobodies from it, and expressed it in E. coli and yeast. The obtained anti-CTLA-4 nanobody has small molecular weight, strong specificity, and strong binding ability to the CTLA-4 extracellular segment, so it can be used for the diagnosis and treatment of tumors with high CTLA-4 expression.
为此,本发明提供了如下技术方案:For this reason, the present invention provides the following technical solutions:
在本发明的第一方面,本发明提供了一种抗CTLA-4纳米抗体,所述纳米抗体选自下列至少之一:(1)具有GYRYSPYC所示的CDR1、IDSDGST所示的CDR2和AADPASFGDCYSGSWSPETI所示的CDR3;(2)与(1)相比,具有至少一个保守氨基酸取代。所提供的抗CTLA-4纳米抗体分子量小,特异性强,与CTLA-4胞外段的结合能力强,可以用于肿瘤的诊断和治疗,尤其是用于CTLA-4高表达的肿瘤的诊断和治疗。In the first aspect of the present invention, the present invention provides an anti-CTLA-4 nanobody selected from at least one of the following: (1) CDR1 shown by GYRYSPYC, CDR2 shown by IDSDGST and AADPASFGDCYSGSWSPETI The CDR3 shown; (2) has at least one conservative amino acid substitution compared to (1). The provided anti-CTLA-4 nanobody has small molecular weight, strong specificity, and strong binding ability to the extracellular segment of CTLA-4, and can be used for tumor diagnosis and treatment, especially for the diagnosis of tumors with high CTLA-4 expression and treatment.
根据本发明的实施例,以上所述的纳米抗体具有如下所示的氨基酸序列:(a)SEQID NO:1所示的氨基酸序列;(b)与(a)相比,具有至少一个保守氨基酸取代。According to an embodiment of the present invention, the above-mentioned Nanobody has the amino acid sequence shown as follows: (a) the amino acid sequence shown in SEQ ID NO: 1; (b) compared with (a), it has at least one conservative amino acid substitution .
在本发明的第二方面,本发明提供了一种核酸,所述核酸包含编码本发明第一方面所述的纳米抗体的核酸序列。In a second aspect of the present invention, the present invention provides a nucleic acid comprising a nucleic acid sequence encoding the Nanobody of the first aspect of the present invention.
根据本发明的实施例,以上所述的核酸还可以进一步包括如下技术特征:According to an embodiment of the present invention, the nucleic acid described above may further include the following technical features:
根据本发明的实施例,所述核酸包含如下所示的核酸序列:SEQ ID NO:2所示的核酸序列;与SEQ ID NO:2所示的核酸序列相比,至少具有95%以上同源性的序列,优选具有98%以上同源性的序列,更优选具有99%以上同源性的序列。According to an embodiment of the present invention, the nucleic acid comprises the following nucleic acid sequence: the nucleic acid sequence shown in SEQ ID NO: 2; compared with the nucleic acid sequence shown in SEQ ID NO: 2, the nucleic acid has at least 95% homology Sequences with homology of 98% or more are preferred, and sequences with homology of 99% or more are more preferred.
在本发明的第三方面,本发明提供了一种表达载体,所述表达载体包含本发明第二方面所述的核酸。In a third aspect of the present invention, the present invention provides an expression vector comprising the nucleic acid according to the second aspect of the present invention.
根据本发明的实施例,所述表达载体进一步包含调节元件,所述调节元件与所述核酸可操作地连接。According to an embodiment of the present invention, the expression vector further comprises a regulatory element operably linked to the nucleic acid.
根据本发明的实施例,所述调节元件包括选自启动子、增强子和终止子中的至少一种。According to an embodiment of the present invention, the regulatory element includes at least one selected from a promoter, an enhancer and a terminator.
在本发明的第四方面,本发明提供了一种重组细胞,所述重组细胞含有本发明第三方面所述的表达载体。In the fourth aspect of the present invention, the present invention provides a recombinant cell containing the expression vector described in the third aspect of the present invention.
在本发明的第五方面,本发明提供了一种生产抗CTLA-4纳米抗体的方法,包括培养本发明第四方面所述的重组细胞,以便获得所述抗CTLA-4纳米抗体。In the fifth aspect of the present invention, the present invention provides a method for producing an anti-CTLA-4 nanobody, comprising culturing the recombinant cells described in the fourth aspect of the present invention, so as to obtain the anti-CTLA-4 nanobody.
在本发明的第六方面,本发明提供了一种纳米抗体在制备治疗肿瘤中的用途,所述纳米抗体为本发明第一方面所述的纳米抗体。In the sixth aspect of the present invention, the present invention provides the use of a nanobody in the preparation of tumor treatment, wherein the nanobody is the nanobody described in the first aspect of the present invention.
根据本发明的实施例,所述肿瘤包括选自前列腺癌,恶性黑素瘤和肺癌中的至少一种。根据本发明的实施例,所述肺癌包括小细胞肺癌和非小细胞肺癌。According to an embodiment of the present invention, the tumor includes at least one selected from the group consisting of prostate cancer, malignant melanoma and lung cancer. According to an embodiment of the present invention, the lung cancer includes small cell lung cancer and non-small cell lung cancer.
在本发明的第七方面,本发明提供了一种药物组合物,所述药物组合物包括本发明第一方面所述的纳米抗体和药学上可接受的载体。In the seventh aspect of the present invention, the present invention provides a pharmaceutical composition comprising the nanobody according to the first aspect of the present invention and a pharmaceutically acceptable carrier.
在本发明的第八方面,本发明提供了一种检测CTLA-4的试剂盒,所述试剂盒包含本发明第一方面所述的纳米抗体。In the eighth aspect of the present invention, the present invention provides a kit for detecting CTLA-4, the kit comprising the nanobody according to the first aspect of the present invention.
在本发明的第九方面,本发明提供了一种Car-T细胞,所述Car-T细胞包括本发明第一方面所述的纳米抗体。应用所提供的含有抗CTLA-4纳米抗体的Car-T细胞对病人进行细胞回输,可以用来治疗肿瘤。In the ninth aspect of the present invention, the present invention provides a Car-T cell, the Car-T cell comprising the nanobody according to the first aspect of the present invention. The provided Car-T cells containing the anti-CTLA-4 nanobody are used to reinfuse the patients, which can be used to treat tumors.
附图说明Description of drawings
图1是根据本发明的实施例提供的经过三轮淘洗的菌落图。FIG. 1 is a diagram of colonies after three rounds of panning provided according to an embodiment of the present invention.
图2是根据本发明的实施例提供的三种抗CTLA-4纳米抗体的表达纯化结果。Figure 2 is the expression and purification results of three anti-CTLA-4 nanobodies provided according to the embodiments of the present invention.
图3是根据本发明的实施例提供的三种抗CTLA-4纳米抗体的特异性检测结果。Figure 3 shows the specific detection results of three anti-CTLA-4 nanobodies provided according to the embodiments of the present invention.
图4是根据本发明的实施例提供的三种抗CTLA-4纳米抗体的热稳定性检测结果。FIG. 4 is the thermal stability test results of three anti-CTLA-4 nanobodies provided according to the embodiments of the present invention.
图5是根据本发明的实施例提供的三种抗CTLA-4纳米抗体与人恶性黑色素瘤细胞A375细胞上CTLA-4结合效率的检测结果图。FIG. 5 is a graph showing the detection results of the binding efficiency of three anti-CTLA-4 nanobodies to CTLA-4 on human malignant melanoma cells A375 cells provided according to an embodiment of the present invention.
具体实施方式Detailed ways
下面详细描述本发明的实施例,需要说明的是,所描述述的实施例是示例性的,旨在用于解释本发明,而不能理解为对本发明的限制。The following describes the embodiments of the present invention in detail. It should be noted that the described embodiments are exemplary and are intended to be used to explain the present invention, but should not be construed as a limitation of the present invention.
同时,为了方便本领域技术人员的理解,对于本文中的一些术语进行了解释和说明。这些解释和说明仅用于方便理解,而不应看做是对本发明保护范围的限制。Meanwhile, for the convenience of understanding by those skilled in the art, some terms in this document are explained and illustrated. These explanations and descriptions are only for the convenience of understanding, and should not be regarded as limiting the protection scope of the present invention.
在本文中,术语“抗体”是指能够与特异性抗原结合的免疫球蛋白分子。通常抗体结构包括两条分子量较轻的轻链和两条分子量较重的重链,重链(H链)和轻链(L链)由二硫键连接形成一个四肽链分子。其中,肽链的氨基端(N端)氨基酸序列变化很大,称为可变区(V区),可变区决定抗体的识别以及与抗原的特异性结合;羧基端(C端)相对稳定,变化很小,称为恒定区(C区),恒定区通常赋予重要的生物学特性,例如抗体链结合、分泌、经胎盘移动性、补体结合和Fc受体结合。重链和轻链的可变区通常称为VH和VL。As used herein, the term "antibody" refers to an immunoglobulin molecule capable of binding to a specific antigen. Generally, the structure of an antibody consists of two light chains with lighter molecular weight and two heavy chains with heavier molecular weight. The heavy chain (H chain) and the light chain (L chain) are connected by disulfide bonds to form a tetrapeptide chain molecule. Among them, the amino-terminal (N-terminal) amino acid sequence of the peptide chain varies greatly, which is called the variable region (V region). The variable region determines the recognition of the antibody and the specific binding with the antigen; the carboxyl-terminal (C-terminal) is relatively stable. , with small changes, known as the constant region (C region), which often confer important biological properties such as antibody chain binding, secretion, transplacental mobility, complement binding and Fc receptor binding. The variable regions of heavy and light chains are commonly referred to as VH and VL.
在可变区中某些区域氨基酸组成和排列顺序具有更高的变化程度,称为高变区(Hypervariable region,HVR),高变区为抗原和抗体结合的位置,因此也称为决定簇互补区(complementarity-determining region,CDR)。重链可变区和轻链可变区上均有三个CDR区。为了表述上的方便,位于重链上的CDR区也称为重链高变区,位于轻链上的CDR区也称为轻链高变区。In the variable region, the amino acid composition and sequence of certain regions have a higher degree of variation, which is called hypervariable region (Hypervariable region, HVR). Complementarity-determining region (CDR). There are three CDR regions on both the heavy chain variable region and the light chain variable region. For the convenience of expression, the CDR region located on the heavy chain is also called the heavy chain hypervariable region, and the CDR region located on the light chain is also called the light chain hypervariable region.
肽链可变区内除了高变区之外的氨基酸组成和排列顺序变化相对较小,称为骨架区(FR)。VH和VL内各有4个骨架区,分别以FR1、FR2、FR3和FR4表示。The amino acid composition and arrangement sequence in the variable region of the peptide chain other than the hypervariable region are relatively small, and are called the framework region (FR). There are four framework regions in VH and VL respectively, which are represented by FR1, FR2, FR3 and FR4 respectively.
纳米抗体(nanobody,a single domain antibody),也称VHH(Variable domainof heavy chain of heavy chain antibody),较早是在骆驼体内存在的天然的缺失轻链的重链抗体,克隆其可变区可以得到只有重链可变区组成的单域抗体,称为VHH。纳米抗体是最小的功能性抗原结合片段,和普通抗体相比,纳米抗体分子量小,结构简单,易于进行基因改造,体积小,抗原特异性好,组织穿透力强,稳定性高,在疾病的诊断及治疗方面有广阔的应用前景。Nanobody (nanobody, a single domain antibody), also known as VHH (Variable domain of heavy chain of heavy antibody chain), is a natural heavy chain antibody lacking light chain that exists in camels earlier, and its variable region can be obtained by cloning Single-domain antibodies composed of only the variable region of the heavy chain are called VHHs. Nanobodies are the smallest functional antigen-binding fragments. Compared with ordinary antibodies, nanobodies have small molecular weight, simple structure, easy genetic modification, small size, good antigen specificity, strong tissue penetration, and high stability. It has broad application prospects in diagnosis and treatment.
在没有轻链的情况下,纳米抗体各自具有三个CDR,分别表示为CDR1、CDR2和CDR3,用来表征纳米抗体的抗原识别和结合的特异性。为此,在本发明的一个方面,本发明提供了一种抗CTL-4纳米抗体,所述纳米抗体包括选自下列至少之一:(1)具有GYRYSPYC所示的CDR1、IDSDGST所示的CDR2和AADPASFGDCYSGSWSPETI所示的CDR3;(2)与(1)相比,具有至少一个保守氨基酸取代。In the absence of a light chain, the Nanobodies each have three CDRs, denoted as CDR1, CDR2 and CDR3, which are used to characterize the specificity of antigen recognition and binding of the Nanobodies. To this end, in one aspect of the present invention, the present invention provides an anti-CTL-4 nanobody, the nanobody comprising at least one selected from the following: (1) CDR1 shown by GYRYSPYC, CDR2 shown by IDSDGST and CDR3 shown in AADPASFGDCYSGSWSPETI; (2) compared with (1), has at least one conservative amino acid substitution.
这些保守氨基酸取代可以发生在CDR1上,也可以发生在CDR2上,或者发生在CDR3上,或者同时发生在CDR1、CDR2或者CDR3上。当然,这些保守氨基酸取代可以是一个氨基酸取代,两个氨基酸取代或者三个氨基酸取代。These conservative amino acid substitutions can occur in CDR1, CDR2, or CDR3, or both CDR1, CDR2, or CDR3. Of course, these conservative amino acid substitutions can be one amino acid substitution, two amino acid substitutions, or three amino acid substitutions.
本文中,所述“保守氨基酸取代”是指纳米抗体中的某些氨基酸或者某几个氨基酸发生改变,而不会损害纳米抗体的整体构象和功能。这些保守氨基酸取代包括使用具有相似的性质(例如,极性、氢键电位、酸度、碱度、疏水性、芳族基团的存在等)的另一种氨基酸替换一种氨基酸。具有相似性质的氨基酸是本领域技术人员熟知的。例如,精氨酸、组氨酸和赖氨酸是亲水-碱性氨基酸并且可以互换。类似地,异亮氨酸(疏水性氨基酸)可以被亮氨酸、蛋氨酸或缬氨酸替换。这种变化对纳米抗体的表观分子量或等电点几乎没有影响或没有影响。再例如一些天然氨基酸可被非天然氨基酸替换,例如D构型的氨基酸、或β或γ氨基酸。Herein, the "conservative amino acid substitution" refers to the change of certain amino acids or a few amino acids in the Nanobody without impairing the overall conformation and function of the Nanobody. These conservative amino acid substitutions include replacing one amino acid with another amino acid having similar properties (eg, polarity, hydrogen bond potential, acidity, basicity, hydrophobicity, presence of aromatic groups, etc.). Amino acids with similar properties are well known to those skilled in the art. For example, arginine, histidine and lysine are hydrophilic-basic amino acids and are interchangeable. Similarly, isoleucine (hydrophobic amino acid) can be replaced by leucine, methionine or valine. This change had little or no effect on the apparent molecular weight or isoelectric point of the Nanobodies. As another example, some natural amino acids may be replaced by unnatural amino acids, such as amino acids in the D configuration, or beta or gamma amino acids.
根据本发明的实施例,所提供的纳米抗体具有如下所示的氨基酸序列:(a)SEQ IDNO:1所示的氨基酸序列;(b)与(a)相比,具有至少一个保守氨基酸取代。According to an embodiment of the present invention, the provided Nanobody has the amino acid sequence shown as follows: (a) the amino acid sequence shown in SEQ ID NO: 1; (b) compared with (a), it has at least one conservative amino acid substitution.
其中SEQ ID NO:1所示的氨基酸序列如下:Wherein the amino acid sequence shown in SEQ ID NO:1 is as follows:
MKYLLPTAAAGLLLLAAQPAMAQVQLQESGGGSVQAGGSLRLSCAASGYRYSPYCMSWFRQSPGKAREGVANIDSDGSTSYADSVKGRFTISKDNAKNTLYLQMNSLKAEDTAMYYCAADPASFGDCYSGSWSPETIWGQGTQVTVSSAAAYPYDVPDYGS(SEQ ID NO:1)。MKYLLPTAAAGLLLLAAQPAMAQVQLQESGGGSVQAGGSLRLSCAASGYRYSPYCMSWFRQSPGKAREGVANIDSDGSTSYADSVKGRFTISKDNAKNTLYLQMNSLKAEDTAMYYCAADPASFGDCYSGSWSPETIWGQGTQVTVSSAAAYPYDVPDYGS (SEQ ID NO: 1).
本发明所提供的抗CTLA-4纳米抗体,其具有热稳定性。例如在37摄氏度条件下处理3小时,其活性至少还保留70%。再例如,在60摄氏度条件下处理3小时,其活性至少还保留60%。本发明所提供的抗CTLA-4纳米抗体相较于抗CTLA-4单克隆抗体来说,稳定性更好,这就为纳米抗体的保存,运输等提供了便利。而且所提供的抗CTLA-4抗体可以用于特殊环境下的检测。另外,所提供的抗CTLA-4纳米抗体也可以用于其他非药用方面,例如应用于洗发水中等等。The anti-CTLA-4 nanobody provided by the present invention has thermal stability. For example, when treated at 37 degrees Celsius for 3 hours, at least 70% of its activity is retained. For another example, at least 60% of its activity is retained at 60 degrees Celsius for 3 hours. Compared with the anti-CTLA-4 monoclonal antibody, the anti-CTLA-4 nanobody provided by the present invention has better stability, which provides convenience for the preservation and transportation of the nanobody. Moreover, the provided anti-CTLA-4 antibody can be used for detection under special circumstances. In addition, the provided anti-CTLA-4 nanobodies can also be used in other non-pharmaceutical applications, such as in shampoos and the like.
在本发明的另一方面,本发明还提供了一种核酸,所述核酸包含编码上述所述抗CTL-4纳米抗体的核酸序列。通常所称的核酸可以是DNA分子,也可以是RNA分子,其可以包含在任何合适的载体中,例如质粒、人工染色体、噬菌体或者病毒载体等。根据本发明的实施例,编码SEQ ID NO:1所示序列的核苷酸序列如SEQ ID NO:2所示。根据本发明的实施例,所提供的核酸序列还可以为与SEQ ID NO:2所示核酸序列相比,至少具有90%以上同源性的序列,例如至少具有95%以上同源性的序列,优选具有98%以上同源性的序列,更优选具有99%以上同源性的序列。In another aspect of the present invention, the present invention also provides a nucleic acid comprising a nucleic acid sequence encoding the above-mentioned anti-CTL-4 nanobody. The so-called nucleic acid can be a DNA molecule or an RNA molecule, which can be contained in any suitable vector, such as a plasmid, an artificial chromosome, a phage or a viral vector, and the like. According to an embodiment of the present invention, the nucleotide sequence encoding the sequence shown in SEQ ID NO:1 is shown in SEQ ID NO:2. According to an embodiment of the present invention, the provided nucleic acid sequence can also be a sequence with at least 90% or more homology compared with the nucleic acid sequence shown in SEQ ID NO: 2, for example, a sequence with at least 95% or more homology , preferably a sequence with more than 98% homology, more preferably a sequence with more than 99% homology.
其中SEQ ID NO:2所示核酸序列如下:Wherein the nucleic acid sequence shown in SEQ ID NO:2 is as follows:
ATGAAATACCTATTGCCTACGGCAGCCGCTGGATTGTTATTACTCGCGGCCCAGCCGGCCATGGCCCAGGTGCAGCTGCAGGAGTCTGGAGGAGGCTCGGTGCAGGCTGGAGGGTCTCTGAGACTCTCCTGTGCAGCCTCTGGATATCGATATAGTCCTTACTGCATGAGCTGGTTCCGACAAAGCCCAGGGAAAGCTCGCGAAGGTGTTGCTAATATCGACAGCGATGGTAGTACTTCCTATGCTGATAGTGTAAAAGGTCGATTTACTATTAGCAAAGATAATGCAAAGAACACTCTATATTTACAAATGAATTCATTAAAAGCCGAAGATACAGCTATGTATTACTGTGCTGCCGATCCCGCCTCCTTTGGTGATTGCTACTCGGGGTCCTGGTCCCCGGAAACAATATGGGGCCAGGGGACCCAGGTCACCGTCTCCTCAGCGGCCGCATACCCGTACGACGTTCCGGACTACGGTTCCTAA(SEQ ID NO:2)。ATGAAATACCTATTGCCTACGGCAGCCGCTGGATTGTTATTACTCGCGGCCCAGCCGGCCATGGCCCAGGTGCAGCTGCAGGAGTCTGGAGGAGGCTCGGTGCAGGCTGGAGGGTCTCTGAGACTCTCCTGTGCAGCCTCTGGATATCGATATAGTCCTTACTGCATGAGCTGGTTCCGACAAAGCCCAGGGAAAGCTCGCGAAGGTGTTGCTAATATCGACAGCGATGGTAGTACTTCCTATGCTGATAGTGTAAAAGGTCGATTTACTATTAGCAAAGATAATGCAAAGAACACTCTATATTTACAAATGAATTCATTAAAAGCCGAAGATACAGCTATGTATTACTGTGCTGCCGATCCCGCCTCCTTTGGTGATTGCTACTCGGGGTCCTGGTCCCCGGAAACAATATGGGGCCAGGGGACCCAGGTCACCGTCTCCTCAGCGGCCGCATACCCGTACGACGTTCCGGACTACGGTTCCTAA(SEQ ID NO:2)。
在本发明的另一方面,本发明提供了一种表达载体,所述载体包含上述核酸。本文中所称的表达载体,在本领域也通常被称为克隆载体或者载体,指可以将DNA序列或者RNA序列引入到宿主细胞的载体,其可以用于转化到宿主细胞中,并促进核酸序列的表达,例如促进转录和翻译。这种表达载体可以包含调节元件,例如启动子、增强子、终止子等,用于引起或指导多肽的表达。用于动物细胞的表达载体的启动子和激活子的实施例包括SV40早期启动子和激活子等。合适的载体可以是质粒,例如一些包含复制起点的质粒或者整合质粒,例如pUC、pcDNA、pBR等。可用的病毒载体包括但不限于腺病毒、逆转录病毒、疱疹病毒和AAV载体。此类病毒载体可通过本领域技术人员熟知的技术生产,例如通过病毒的瞬时转染或者稳定转染获得。在进行病毒转染时,可用到的转染细胞可以是PA317细胞、PsiCRIP细胞、GPenv+细胞、293细胞等。In another aspect of the present invention, the present invention provides an expression vector comprising the above-mentioned nucleic acid. Expression vectors referred to herein, also commonly referred to in the art as cloning vectors or vectors, refer to vectors that can introduce DNA sequences or RNA sequences into host cells, which can be used for transformation into host cells and facilitate nucleic acid sequences expression, such as promoting transcription and translation. Such expression vectors may contain regulatory elements, such as promoters, enhancers, terminators, etc., for causing or directing the expression of the polypeptide. Examples of promoters and activators of expression vectors for animal cells include the SV40 early promoter and activator, and the like. Suitable vectors may be plasmids, such as some containing origins of replication or integrating plasmids, such as pUC, pcDNA, pBR, and the like. Useful viral vectors include, but are not limited to, adenovirus, retrovirus, herpesvirus, and AAV vectors. Such viral vectors can be produced by techniques well known to those skilled in the art, such as by transient or stable transfection of viruses. In the case of virus transfection, the transfected cells that can be used can be PA317 cells, PsiCRIP cells, GPenv+ cells, 293 cells and the like.
在本发明的另一方面,本发明提供了一种重组细胞,所述重组细胞含有上述所述的表达载体。所提供的重组细胞可以通过将表达载体转化到宿主细胞中获得。例如可以通过表达载体将外源基因或者DNA序列或者RNA序列引入到宿主细胞中,以便使得宿主细胞表达所引入的基因或者序列,来产生想要的物质,这些想要的物质通常是由基因或者引入序列所编码的蛋白质。常用的宿主细胞包括但不限于大肠杆菌宿主细胞(在导入时常用质粒载体)、昆虫宿主细胞(在导入时常用杆状病毒载体),以及哺乳动物宿主细胞。例如,还可以包括原核细胞(例如细菌)和真核细胞(例如酵母细胞、哺乳动物细胞、昆虫细胞、植物细胞等)。具体的哺乳动物宿主细胞可以为Vero细胞、CHO细胞、3T3细胞、COS细胞等。In another aspect of the present invention, the present invention provides a recombinant cell containing the above-mentioned expression vector. The provided recombinant cells can be obtained by transforming the expression vector into a host cell. For example, an exogenous gene or DNA sequence or RNA sequence can be introduced into a host cell by means of an expression vector, so that the host cell expresses the introduced gene or sequence to produce the desired substance, which is usually expressed by the gene or The protein encoded by the introduced sequence. Commonly used host cells include, but are not limited to, E. coli host cells (where plasmid vectors are typically used for introduction), insect host cells (where baculovirus vectors are typically used for introduction), and mammalian host cells. For example, prokaryotic cells (eg, bacteria) and eukaryotic cells (eg, yeast cells, mammalian cells, insect cells, plant cells, etc.) may also be included. Specific mammalian host cells can be Vero cells, CHO cells, 3T3 cells, COS cells and the like.
通过在合适的条件下培养上述提供的重组细胞,可以获得所述抗CTLA-4纳米抗体。在培养所述重组细胞时,可以采用本领域技术人员已知的任何生产技术,例如任何化学上、生物学上、遗传学上或者酶学技术,这些技术可以单独或者组合应用。所获得的抗CTLA-4纳米抗体可以通过常规的蛋白纯化方法进行分离和纯化,例如可以通过羟基磷灰石层析、凝胶电泳、亲和透析或色谱法等常规的蛋白纯化方法进行分离和纯化。The anti-CTLA-4 Nanobody can be obtained by culturing the recombinant cells provided above under suitable conditions. In culturing the recombinant cells, any production technique known to those skilled in the art can be employed, such as any chemical, biological, genetic or enzymatic technique, either alone or in combination. The obtained anti-CTLA-4 nanobodies can be separated and purified by conventional protein purification methods, for example, by conventional protein purification methods such as hydroxyapatite chromatography, gel electrophoresis, affinity dialysis or chromatography. purification.
本发明所提供的抗CTLA-4纳米抗体可以用来治疗CTLA-4过表达为特征的疾病,例如肿瘤,包括但不限于前列腺癌,恶性黑素瘤和肺癌(小细胞和非小细胞)等。例如,还可以为卵巢癌、结肠癌、直肠癌、肾癌、膀胱癌、乳腺癌、肝癌、淋巴癌、恶性血液病、头颈癌、胃癌、胶质瘤、鼻咽癌、喉癌、宫颈癌、子宫体瘤和骨肉瘤等等。The anti-CTLA-4 nanobodies provided by the present invention can be used to treat diseases characterized by CTLA-4 overexpression, such as tumors, including but not limited to prostate cancer, malignant melanoma and lung cancer (small cell and non-small cell), etc. . For example, ovarian cancer, colon cancer, rectal cancer, kidney cancer, bladder cancer, breast cancer, liver cancer, lymphoma, hematological malignancies, head and neck cancer, gastric cancer, glioma, nasopharyngeal cancer, laryngeal cancer, cervical cancer , uterine tumor and osteosarcoma, etc.
在本发明的又一方面,本发明提供了一种药物组合物,所述药物组合物包括上述抗CTLA-4纳米抗体和药学上可接受的载体。术语“药学上可接受的载体”是指药学上可用的辅助成药的成分,例如可以包括任何溶剂、分散介质、包衣、抗细菌或抗真菌剂、等渗剂或吸收延迟剂等等。这些药学上可接受的载体的功能和用途是本领域技术人员公知的。本领域技术人员可以根据这些药学上可接受的载体的功能和用途,与抗CTLA-4纳米抗体复配,获得相应的药物组合物,用作制药或者疾病的治疗领域。所提供的药物组合物可以是不同的剂型,例如可以通过口服,通过吸入,肠胃外(特别是通过静脉内注射)等合适的形式施用。当肠胃外途径时,所提供的抗CTLA-4纳米抗体可以是以包装在小瓶中以可注射溶质和悬浮液的形式提供。通常可以将抗CTLA-4纳米抗体与缓冲剂、稳定剂、防腐剂、增溶剂、等渗剂和悬浮剂等混合来获得肠胃外施用的形式。混合后的各物质进行灭菌,然后以静脉内注射剂的形式包装。可用的缓冲剂可以是有机磷酸盐。可用的悬浮剂可以是甲基纤维素、羟乙基纤维素、羟丙基纤维素、阿拉伯树胶和/或羧甲基纤维素钠。此外,可用的稳定剂可以是亚硫酸钠和偏亚硫酸氢钠,可用的防腐剂可以是对羟基苯甲酸钠、山梨酸、甲酚和氯甲酚等。In yet another aspect of the present invention, the present invention provides a pharmaceutical composition comprising the above-mentioned anti-CTLA-4 nanobody and a pharmaceutically acceptable carrier. The term "pharmaceutically acceptable carrier" refers to a pharmaceutically acceptable accessory ingredient, which may include, for example, any solvents, dispersion media, coatings, antibacterial or antifungal agents, isotonic or absorption delaying agents, and the like. The function and use of these pharmaceutically acceptable carriers are well known to those skilled in the art. Those skilled in the art can, according to the functions and uses of these pharmaceutically acceptable carriers, compound with anti-CTLA-4 nanobodies to obtain corresponding pharmaceutical compositions, which can be used in the field of pharmacy or disease treatment. The provided pharmaceutical compositions can be in various dosage forms, for example, can be administered orally, by inhalation, parenterally (especially by intravenous injection) and the like in a suitable form. When the parenteral route is used, the provided anti-CTLA-4 Nanobodies can be provided in the form of injectable solutes and suspensions packaged in vials. Forms for parenteral administration can generally be obtained by admixing the anti-CTLA-4 Nanobodies with buffers, stabilizers, preservatives, solubilizers, isotonic and suspending agents, and the like. The mixed substances are sterilized and then packaged in the form of intravenous injections. Useful buffers can be organophosphates. Useful suspending agents may be methylcellulose, hydroxyethylcellulose, hydroxypropylcellulose, acacia and/or sodium carboxymethylcellulose. In addition, usable stabilizers may be sodium sulfite and sodium metabisulfite, and usable preservatives may be sodium paraben, sorbic acid, cresol, chlorocresol, and the like.
本发明的药物组合物也可以在联合治疗中施用,即与其他药剂联用。例如,联合治疗可包括本发明的抗CTLA-4纳米抗体联合至少一种其他的抗肿瘤药物。例如,本发明所提供的抗CTLA-4纳米抗体可以与靶向其他肿瘤特异性抗原的抗体联合使用。所述靶向其他肿瘤特异性抗原的抗体包括但不限于抗EGFR抗体、抗HER2抗体、抗VEGFa抗体等等,这些抗体优选是单克隆抗体。本发明所提供的抗CTLA-4纳米抗体还可以与其他肿瘤免疫治疗手段、或者肿瘤靶向性小分子类药物联用。所述其他肿瘤免疫治疗手段包括但不限于针对肿瘤免疫调节分子,例如OX40、PDL1/PD1、CD137等治疗型抗体,或者CAR-T治疗手段等。The pharmaceutical compositions of the present invention may also be administered in combination therapy, ie in combination with other agents. For example, a combination therapy can include an anti-CTLA-4 Nanobody of the invention in combination with at least one other anti-tumor drug. For example, the anti-CTLA-4 Nanobodies provided by the present invention can be used in combination with antibodies targeting other tumor-specific antigens. The antibodies targeting other tumor-specific antigens include, but are not limited to, anti-EGFR antibodies, anti-HER2 antibodies, anti-VEGFa antibodies, etc. These antibodies are preferably monoclonal antibodies. The anti-CTLA-4 nanobody provided by the present invention can also be used in combination with other tumor immunotherapy methods or tumor-targeted small molecule drugs. The other tumor immunotherapy methods include, but are not limited to, tumor immune regulatory molecules, such as therapeutic antibodies such as OX40, PDL1/PD1, CD137, or CAR-T therapy methods.
所提供的药物组合物也可以与其他肿瘤治疗手段,例如放化疗、手术治疗等联用使用,或者在放化疗或者手术治疗之前或者之后使用。The provided pharmaceutical composition can also be used in combination with other tumor treatment methods, such as radiochemotherapy, surgery, etc., or before or after radiotherapy, chemotherapy or surgery.
药物组合物中的抗CTLA-4纳米抗体的剂量范围可以为0.0001至100mg/kg,更通常为0.01至20mg/kg对象体重。例如,剂量可以为0.2mg/kg体重、0.5mg/kg体重、1mg/kg体重、3mg/kg体重、5mg/kg体重、8mg/kg体重、10mg/kg体重、15mg/kg体重、20.2mg/kg体重或者30mg/kg体重,或者是在1-30mg/kg体重范围内。治疗或者用药时,可以采用每周给药一次、每两周给药一次、每三周给药一次、每四周一次等等。The dosage of the anti-CTLA-4 Nanobody in the pharmaceutical composition may range from 0.0001 to 100 mg/kg, more typically 0.01 to 20 mg/kg of the subject's body weight. For example, doses can be 0.2 mg/kg body weight, 0.5 mg/kg body weight, 1 mg/kg body weight, 3 mg/kg body weight, 5 mg/kg body weight, 8 mg/kg body weight, 10 mg/kg body weight, 15 mg/kg body weight, 20.2 mg/kg body weight kg body weight or 30 mg/kg body weight, or within the range of 1-30 mg/kg body weight. For treatment or administration, weekly dosing, bi-weekly dosing, three-week dosing, every four-week dosing, and the like can be employed.
当然所提供的抗CTLA-4纳米抗体还可以作为试剂盒的一部分,用于检测CTLA-4。所提供的试剂盒除了含有抗CTLA-4纳米抗体之外,还可以含有本领域常用的用作抗原检测的常规试剂。Of course, the anti-CTLA-4 nanobodies provided can also be used as part of the kit to detect CTLA-4. In addition to the anti-CTLA-4 nanobody, the provided kit may also contain conventional reagents commonly used in the art for antigen detection.
在本发明的另一方面,本发明还提供了一种预防和/或治疗癌症的方法,所述方法包括给予对象有效量的药物组合物或者有效量的纳米抗体,所述药物组合物上述提供的药物组合物,所述纳米抗体为上述提供的纳米抗体。本文中所提到的“有效量的”优选可以使得对象中细胞生长或者肿瘤生长抑制至少10%,优选至少20%,更优选至少30%,更优选至少40%,更优选至少50%,更优选至少60%,更优选至少70%,更优选至少80%。有效量的药物组合物或者有效量的纳米抗体能够减少肿瘤大小,或者以其他方式缓解对象的症状,例如实现或者延长肿瘤患者的无进展生存期等。In another aspect of the present invention, the present invention also provides a method for preventing and/or treating cancer, the method comprising administering to a subject an effective amount of a pharmaceutical composition or an effective amount of a Nanobody, the pharmaceutical composition provided above The pharmaceutical composition, the nanobody is the nanobody provided above. An "effective amount" as referred to herein preferably results in at least 10% inhibition of cell growth or tumor growth in a subject, preferably at least 20%, more preferably at least 30%, more preferably at least 40%, more preferably at least 50%, even more Preferably at least 60%, more preferably at least 70%, more preferably at least 80%. An effective amount of the pharmaceutical composition or an effective amount of the Nanobody can reduce the tumor size, or alleviate the symptoms of the subject in other ways, such as achieving or prolonging the progression-free survival of tumor patients.
需要说明的是,根据上述所提供的抗CTLA-4纳米抗体可以应用于生物医药的研发,用作临床诊断,用作肿瘤的研究、治疗以及用作免疫学的研究和治疗上。例如,不仅仅可以应用到上述提到的各个产品,例如药物组合物,试剂盒等等,还可以结合本领域常用的技术,改造成多价抗体或者多特异性纳米抗体的形式。也可以应用于制备Car-T细胞。这些Car-T细胞可以通过基因工程的常用手段获得,从而可以应用该Car-T细胞回输到病人体内,治疗肿瘤。It should be noted that the anti-CTLA-4 nanobodies provided above can be applied to the research and development of biomedicine, used for clinical diagnosis, used for tumor research and treatment, and used for immunology research and treatment. For example, it can not only be applied to the above-mentioned products, such as pharmaceutical compositions, kits, etc., but also can be transformed into the form of multivalent antibodies or multispecific nanobodies in combination with techniques commonly used in the art. It can also be used to prepare Car-T cells. These Car-T cells can be obtained by common means of genetic engineering, so that the Car-T cells can be used to infuse patients into the body to treat tumors.
下面将结合实施例对本发明的方案进行解释。本领域技术人员将会理解,下面的实施例仅用于说明本发明,而不应视为限定本发明的范围。实施例中未注明具体技术或条件的,按照本领域内的文献所描述的技术或条件或者按照产品说明书进行。所用试剂或仪器未注明生产厂商者,均为可以通过市购获得的常规产品。The solution of the present invention will be explained below in conjunction with the embodiments. Those skilled in the art will understand that the following examples are only used to illustrate the present invention, and should not be construed as limiting the scope of the present invention. If no specific technique or condition is indicated in the examples, the technique or condition described in the literature in the field or the product specification is used. The reagents or instruments used without the manufacturer's indication are conventional products that can be obtained from the market.
实施例1噬菌体纳米抗体文库的制备Example 1 Preparation of phage Nanobody library
(1)采取两只未经任何免疫抗原的双峰驼的血液,每只取100mL,将收集的血液与等体积的生理盐水混匀,将稀释后的血液缓慢加入到淋巴细胞分离液的表面,室温2000rpm离心20min。吸取第二层的淋巴细胞,加入五倍体积的PBS,室温2000rpm离心20min,重复三次。将收集下来的淋巴细胞加入1mL的Trizol(购于Invitrogen,货号为15596026)试剂,重复混匀,于12000rpm、4℃离心15min。再向离心后上清中加入0.2mL的氯仿,充分混匀后静置3min,于12000rpm、4℃离心15min。吸取最上层水相与等体积的异丙醇混匀,静置10min,于12000rpm、4℃离心10min。去上清,再加入1mL预冷的75%乙醇,洗涤沉淀,于12000rpm、4℃离心10min。再加入100μL的DEPC水溶解。(1) Take the blood of two Bactrian camels without any immunization antigen, take 100 mL each, mix the collected blood with an equal volume of normal saline, and slowly add the diluted blood to the surface of the lymphocyte separation solution , and centrifuged at 2000 rpm for 20 min at room temperature. The lymphocytes in the second layer were aspirated, five times the volume of PBS was added, and centrifugation was performed at room temperature at 2000 rpm for 20 min, repeated three times. The collected lymphocytes were added to 1 mL of Trizol (purchased from Invitrogen, the product number is 15596026) reagent, mixed repeatedly, and centrifuged at 12000 rpm and 4° C. for 15 min. Then, 0.2 mL of chloroform was added to the supernatant after centrifugation, thoroughly mixed, and then left to stand for 3 min, and then centrifuged at 12,000 rpm and 4° C. for 15 min. Pipette the uppermost aqueous phase and mix with an equal volume of isopropanol, let stand for 10 min, and centrifuge at 12000 rpm and 4 °C for 10 min. The supernatant was removed, 1 mL of pre-cooled 75% ethanol was added, the precipitate was washed, and centrifuged at 12,000 rpm and 4° C. for 10 min. Then add 100 μL of DEPC water to dissolve.
(2)采用AMV First Strand cDNA Synthesis Kit(购于NEB,货号为E6550S)将上述RNA逆转录为DNA。(2) The above RNA was reverse transcribed into DNA using AMV First Strand cDNA Synthesis Kit (purchased from NEB, product number E6550S).
第一步体系条件如下:The first system conditions are as follows:
第二步体系条件如下:The system conditions for the second step are as follows:
(3)利用KAPA HiFi HotStart ReadyMix PCR Kit(购于KAPA,货号为KK2611)通过PCR的方法扩增VHH基因。而且由于骆驼抗体有两种模板,两种模板的C端略有不同,所以使用两个R-primer,来获得更多更全面的抗体。(3) The VHH gene was amplified by PCR using the KAPA HiFi HotStart ReadyMix PCR Kit (purchased from KAPA, the product number is KK2611). And because camelid antibodies have two templates, and the C-terminals of the two templates are slightly different, two R-primers are used to obtain more and more comprehensive antibodies.
反应条件:Reaction conditions:
F-primer:5′F-primer: 5′
-GAGGAGGAGGAGGAGGTGGCCCAGGCGGCCCAGGTSMARCTGCAGSAGTCWGG-3′(SEQ ID NO:3)。其中S代表碱基G或C,W代表碱基A或T,M代表碱基A或C,R代表碱基G或A。-GAGGAGGAGGAGGAGGTGGCCCAGGCGGCCCAGGTSMARCTGCAGSAGTCWGG-3' (SEQ ID NO: 3). Where S represents the base G or C, W represents the base A or T, M represents the base A or C, and R represents the base G or A.
R-primer1:5′R-primer1:5′
-GAGGAGGAGGAGGAGGTGGCCCAGGCGGCCGGAGCTGGGGTCTTCGCTGTGGTGCG-3′(SEQ IDNO:4)。-GAGGAGGAGGAGGAGGTGGCCCAGGCGGCCGGAGCTGGGGTCTTCGCTGTGGTGCG-3' (SEQ ID NO:4).
R-primer2:5′R-primer2:5′
-GAGGAGGAGGAGGAGGTGGCCCAGGCGGCCTGGTTGTGGTTTTGGTGTCTTGGGTT-3′(SEQ IDNO:5)。-GAGGAGGAGGAGGAGGTGGCCCAGGCGGCCTGGTTGTGGTTTTGGTGTCTTGGGTT-3' (SEQ ID NO: 5).
(4)使用SfiⅠ(购于Takara,货号为1244A)内切酶对pComb-3X载体(购于AlleleBiotechnology and Pharmaceuticals)和VHH基因酶切,反应体系和条件如下:(4) The pComb-3X vector (purchased from AlleleBiotechnology and Pharmaceuticals) and VHH gene were digested with SfiI (purchased from Takara, the product number is 1244A) endonuclease, and the reaction system and conditions were as follows:
(5)用T4 DNA Ligase对pComb-3X载体和VHH基因进行连接。反应体系条件如下:(5) The pComb-3X vector and the VHH gene were ligated with T4 DNA Ligase. The reaction system conditions are as follows:
(6)将0.2μL的上述连接产物与90μL TG1感受态菌液中,混匀加入电转杯,1900V电转5ms后,加入1mL SOC培养基(购于Sangon Biotech,货号为A507009),37℃摇床中,250rpm培养1h。再加入10mL SOC培养基,继续培养1h。向其中加入2mL VCSM13辅助噬菌体(购于Biovector)的同时,加入含终浓度为10μg/mL氨苄青霉素(Amp,购于Sangon Biotech,货号为A610028)抗性的200mL SOC培养基,继续培养2h。之后加入终浓度为10μg/mL卡那霉素(Kana,购于Sangon Biotech,货号为A600286)培养过夜。(6) Mix 0.2 μL of the above-mentioned ligation product and 90 μL of TG1 competent bacterial solution, and add it to the electroporation cup. After electroporation at 1900V for 5 ms, add 1 mL of SOC medium (purchased from Sangon Biotech, product number A507009), shake at 37°C medium, cultured at 250 rpm for 1 h. Then 10 mL of SOC medium was added, and the culture was continued for 1 h. While adding 2 mL of VCSM13 helper phage (purchased from Biovector), 200 mL of SOC medium containing resistance to ampicillin (Amp, purchased from Sangon Biotech, product number A610028) at a final concentration of 10 μg/mL was added, and the culture was continued for 2 h. Then, kanamycin (Kana, purchased from Sangon Biotech, product number A600286) at a final concentration of 10 μg/mL was added and cultured overnight.
(7)将上述培养过夜的TG1菌液于4℃,3000g离心15min。将离心后的上清和PEG6000(购于Biosharp,货号为BY0027)/NaCl(购于Macklin,货号为S805275)溶液以6:1的比例混匀,冰上静置30min。2200×g离心30min,沉淀再用2mL PBS溶液重悬。再4℃,13200rpm离心5min。再用0.22μm滤膜(购于Merck Millipore,货号为SLGP033RB)过滤上清以用于淘洗实验。(7) Centrifuge the TG1 bacterial liquid cultured overnight at 4°C and 3000 g for 15 min. The supernatant after centrifugation and the PEG6000 (purchased from Biosharp, product number BY0027)/NaCl (purchased from Macklin, product number S805275) solution were mixed at a ratio of 6:1, and allowed to stand on ice for 30 min. Centrifuge at 2200 × g for 30 min, and resuspend the pellet with 2 mL of PBS solution. Then centrifuge at 13200rpm for 5min at 4°C. The supernatant was then filtered through a 0.22 μm filter (purchased from Merck Millipore, Cat. No. SLGP033RB) for panning experiments.
实施例2噬菌体纳米抗体文库淘洗Example 2 Phage Nanobody Library Panning
对实施例1所获得的噬菌体纳米文库进行淘洗,包括如下步骤:The phage nano-libraries obtained in Example 1 were panned, including the following steps:
(1)用NaHCO3包被液(购于Sigma,货号为s6297)稀释CTLA-4(购于义翘神州,货号为90213-C08H)蛋白,以每孔20μg CTLA-4蛋白偶联在酶标板中,4℃过夜,并设置阴性对照。(1) Dilute the CTLA-4 protein (purchased from Yiqiao Shenzhou, the product number is 90213-C08H) with NaHCO3 coating solution (purchased from Sigma, the product number is 90213-C08H), and couple 20 μg CTLA-4 protein per well on the enzyme label plate at 4°C overnight and set up a negative control.
(2)次日,吸取酶标板中未偶联的目的蛋白,再加入300μL 0.1%PBST,静置3min(洗板一次),再向酶标板中加入含2%脱脂奶粉,37℃封闭2h,再用300μL 0.1%PBST溶液洗板一次,静置3min。(2) The next day, aspirate the unconjugated target protein in the ELISA plate, add 300 μL of 0.1% PBST, let it stand for 3 minutes (wash the plate once), add 2% nonfat milk powder to the ELISA plate, and block at 37°C After 2 h, the plate was washed once with 300 μL of 0.1% PBST solution, and left for 3 min.
(3)取300μL制备的纳米抗体噬菌体文库于等体积的2%脱脂奶粉混匀,每孔加入100μL的上述混合液,37℃孵育1h。(3) Mix 300 μL of the prepared nanobody phage library with an equal volume of 2% nonfat dry milk, add 100 μL of the above mixture to each well, and incubate at 37° C. for 1 h.
(8)每孔加入300μL 0.1%PBST溶液洗板5至15次,每次静置3min(根据淘洗轮数的递增,洗板次数也相应递增,最后一次淘洗,偶联抗原的浓度减半),进行三轮淘洗实验。(8) Add 300 μL of 0.1% PBST solution to each well to wash the plate 5 to 15 times, and let stand for 3 min each time (according to the increase of the number of elutriation rounds, the number of plate washing will also increase accordingly, the last elutriation, the concentration of the conjugated antigen decreases half), three rounds of panning experiments were performed.
(4)每孔加入100μL 100mM三乙胺(TES,购于aladdin)溶液,放置于室温孵育10min。将上清中解离的噬菌体继续感染TG1菌株,在多轮淘洗的过程中不断富集,以便筛选出特异性好、亲和力高的纳米抗体序列。(4) 100 μL of 100 mM triethylamine (TES, purchased from aladdin) solution was added to each well, and incubated at room temperature for 10 min. The dissociated phages in the supernatant were continued to infect the TG1 strain, and were continuously enriched in the process of multiple rounds of panning, so as to screen out nanobody sequences with good specificity and high affinity.
图1显示三轮淘洗的菌落图,其中图1中1.9×105CFU代表经过第一轮淘洗所获得的菌落数,3.9×104CFU代表经过第二轮淘洗所获得的菌落数,1.6×106CFU代表经过第三轮淘洗所获得的菌落数。结果表明,经过三轮淘洗后的库容量逐渐增加。Figure 1 shows the colony map of three rounds of panning, wherein 1.9×105 CFU in Figure 1 represents the number of colonies obtained after the first round of panning, and 3.9×104 CFU represents the number of colonies obtained after the second round of panning , 1.6×106 CFU represents the number of colonies obtained after the third round of panning. The results showed that the library capacity gradually increased after three rounds of panning.
实施例3噬菌体纳米抗体文库筛选抗CTLA-4纳米抗体Example 3 Phage Nanobody Library Screening Anti-CTLA-4 Nanobody
利用经过淘洗的噬菌体纳米抗体文库筛选抗CTLA-4纳米抗体,包括如下步骤:Screening of anti-CTLA-4 Nanobodies using the panned phage Nanobody library, including the following steps:
(1)随机挑选淘洗的最后一轮平板上的不同单菌落接种含1mL/孔2×YT培养基(购于Sangon Biotech,货号为A507016)的96孔深孔板(购于NUNC,货号为95040452)中,并在平板上做好标记。37℃,150rpm培养3h,之后加入1mM IPTG(购于Solarbio,货号为I8070),28℃、150rpm过夜诱导。(1) Randomly select different single colonies on the plate in the last round of panning and inoculate a 96-well deep-well plate (purchased from NUNC, product number: 95040452) and mark it on the plate. Incubate at 37°C and 150rpm for 3h, then add 1mM IPTG (purchased from Solarbio, catalog number I8070), and induce overnight at 28°C and 150rpm.
(2)用NaHCO3包被液稀释CTLA-4蛋白,以100ng CTLA-4蛋白偶联在酶标板中,4℃过夜,并设置相应的阴性对照。(2) The CTLA-4 protein was diluted with NaHCO3 coating solution, 100 ng CTLA-4 protein was coupled to the ELISA plate, overnight at 4°C, and the corresponding negative control was set.
(3)次日,用0.1%PBST洗板,静置3min,再向酶标板中加入2%脱脂奶粉,37℃封闭2h,用0.1%PBST溶液洗板一次,同时将过夜诱导的深孔板于4℃,4000rpm,离心30min。吸去上清,每孔的沉淀各用200μL TES溶液重悬,4℃,150rpm,孵育2h。(3) The next day, wash the plate with 0.1% PBST, let it stand for 3 minutes, then add 2% nonfat milk powder to the ELISA plate, block at 37°C for 2 hours, wash the plate once with 0.1% PBST solution, and at the same time, the deep well induced overnight Plates were centrifuged for 30 min at 4000 rpm at 4°C. The supernatant was aspirated, the pellets in each well were resuspended with 200 μL of TES solution, and incubated at 4° C., 150 rpm for 2 h.
(4)继续向每孔加入300μL TES/4溶液,放置于4℃,150rpm孵育2h。再将深孔板放置于4℃,4000rpm,离心30min。将上述上清以100μL分别加入到相应的含有目的蛋白的孔中以及阴性对照孔中,37℃孵育1h。(4) Continue to add 300 μL of TES/4 solution to each well, place at 4° C. and incubate at 150 rpm for 2 h. The deep-well plate was then placed at 4° C., 4000 rpm, and centrifuged for 30 min. 100 μL of the above supernatant was added to the corresponding wells containing the target protein and the negative control wells, respectively, and incubated at 37° C. for 1 h.
(5)每孔加入300μL 0.1%PBST溶液洗板,洗板三次,每次静置3min,去掉未结合的抗体,每孔加入100μL 1:5000稀释的anti-HA-HRP(购于GNI,GNI4310-HA-S),37℃孵育1h。(5) Add 300 μL of 0.1% PBST solution to each well to wash the plate, wash the plate three times, let stand for 3 min each time, remove the unbound antibody, and add 100 μL of 1:5000 diluted anti-HA-HRP (purchased from GNI, GNI4310) to each well -HA-S), incubated at 37°C for 1 h.
(6)每孔加入300μL 0.1%PBST溶液洗板,洗板三次,每次静置3min,以去掉未结合的抗体,每孔再加入100μL TMB(购于湖州英创,TMB-S-004)显色剂,37℃避光孵育10min,每孔再加入100μL 2.29%硫酸(购于广州化学试剂厂)终止反应。(6) Add 300 μL of 0.1% PBST solution to each well to wash the plate, wash the plate three times, and stand for 3 minutes each time to remove unbound antibodies, and then add 100 μL of TMB (purchased from Huzhou Intron, TMB-S-004) to each well. The chromogenic reagent was incubated at 37°C for 10 min in the dark, and 100 μL of 2.29% sulfuric acid (purchased from Guangzhou Chemical Reagent Factory) was added to each well to terminate the reaction.
(7)用酶标仪测OD450nm波长处的值,抗原孔是空白孔吸光值的两倍,则视为阳性。(7) Measure the value at the wavelength of OD450nm with a microplate reader, if the absorbance value of the antigen well is twice that of the blank well, it is regarded as positive.
(8)阳性转化子接种到10mL LB培养基(购于Sangon Biotech,货号为A507002)中,37℃,150rpm培养8h,收集菌液并送测序(Sangon Biotech)。(8) The positive transformants were inoculated into 10 mL of LB medium (purchased from Sangon Biotech, product number A507002), cultured at 37° C., 150 rpm for 8 h, and the bacterial liquid was collected and sent for sequencing (Sangon Biotech).
根据测序结果,用BLAST进行序列比对,将互补决定区序列高度相近的序列视为一株,最终筛选得到一株特异性抗CTLA-4纳米抗体。为了表述方便,纳米抗体分别命名为G4纳米抗体,经测定,G4纳米抗体的氨基酸序列经测定如SEQ ID NO:1所示,编码SEQ ID NO:1所示序列的核酸序列如SEQ ID NO:2所示。According to the sequencing results, BLAST was used for sequence alignment, and the sequences with highly similar complementarity determining regions were regarded as one strain, and a specific anti-CTLA-4 nanobody was finally screened. For the convenience of expression, the Nanobodies are named as G4 Nanobodies respectively. After determination, the amino acid sequence of G4 Nanobodies is determined as shown in SEQ ID NO: 1, and the nucleic acid sequence encoding the sequence shown in SEQ ID NO: 1 is shown in SEQ ID NO: 2 shown.
实施例4抗CTLA-4纳米抗体的表达纯化Example 4 Expression and purification of anti-CTLA-4 nanobody
(1)将上述阳性转化子质粒以1800V的电压电转至WK6菌株(购于BioVector NTCC质粒载体菌种细胞基因保藏中心)中,涂布在Amp抗性的LB平板上,过夜培养,第二天,挑取平板上的单菌落接种到10mL含有Amp抗性的LB培养基中,37℃、220rpm培养8h。(1) The above-mentioned positive transformant plasmid was electroporated into WK6 strain (purchased from BioVector NTCC plasmid carrier strain cell gene collection center) at a voltage of 1800V, spread on Amp-resistant LB plate, cultured overnight, and the next day , pick a single colony on the plate and inoculate it into 10 mL of LB medium containing Amp resistance, and cultivate at 37°C and 220 rpm for 8 h.
(2)将上述菌液接种到330mL含有Amp抗性的TB培养基(购于ELITE-MEDIA,货号为M201-02)中,37℃,220rpm培养至OD=0.7-0.8。再加入终浓度为1mM IPTG,28℃、220rpm诱导过夜。(2) The above bacterial liquid was inoculated into 330 mL of Amp-resistant TB medium (purchased from ELITE-MEDIA, product number M201-02), and cultured at 37° C. and 220 rpm to OD=0.7-0.8. Then add the final concentration of 1mM IPTG, and induce overnight at 28°C and 220rpm.
(3)第二天,收集菌体,PBS重悬再离心。最后用菌体质量比TES溶液体积比1:10的比列重悬菌体,利用渗透压法破碎菌体。10000rpm离心30min,收集上清提取物。再用0.45μm滤膜进行过滤除菌体碎片。(3) On the second day, the cells were collected, resuspended in PBS and centrifuged. Finally, the cells were resuspended in a ratio of 1:10 of the mass of the cells to the volume of the TES solution, and the cells were broken by the osmotic pressure method. Centrifuge at 10,000 rpm for 30 min, and collect the supernatant extract. Then use a 0.45 μm filter to remove bacterial fragments.
(4)使用AKTA纯化仪(购于GE)进行镍柱亲和层析,首先,用流速为1mL/min的PBS溶液对镍柱(购于GE,货号为10230759)进行平衡,直到UV280值保持不变,再以1mL/min的流速上样,再用流速为1mL/min的PBS溶液对镍柱进行平衡,直到UV280值保持不变,分别用20mM、100mM、150mM、200mM、250mM和500mM咪唑以1mL/min的流速的对杂蛋白以及目的蛋白进行洗脱。(4) Use AKTA purifier (purchased from GE) to conduct nickel column affinity chromatography. First, equilibrate the nickel column (purchased from GE, product number 10230759) with PBS solution with a flow rate of 1 mL/min until the UV280 value is maintained The nickel column was equilibrated with PBS solution at a flow rate of 1 mL/min until the UV280 value remained unchanged, and the samples were loaded at a flow rate of 1 mL/min. The impurity and target proteins were eluted at a flow rate of 1 mL/min.
(5)使用预制胶(购于invitrogen,货号为EC6025BOX)进行电泳,取制备好的样品20μL加入到预制胶中,80V电压30min使样品电泳至分离胶,然后120V电压电泳直到指示剂到底部停止电泳。将胶浸泡在考马斯亮兰溶液(购于Solarbio,货号为P1305)中1h,再用脱色液脱色(购于Solarbio,货号为P1305)直到可以看到清晰的蛋白条带,最终获得纯化后的G4纳米抗体,经Image J软件分析,其纯度为95%,图2为特异性抗CTLA-4纳米抗体的表达纯化结果。(5) Use a precast gel (purchased from invitrogen, the product number is EC6025BOX) for electrophoresis, add 20 μL of the prepared sample to the precast gel, electrophoresis the sample to the separation gel at 80V for 30 minutes, and then electrophoresis at 120V until the indicator stops at the bottom electrophoresis. Soak the gel in Coomassie brilliant blue solution (purchased from Solarbio, product number P1305) for 1 h, and then decolorize with decolorizing solution (purchased from Solarbio, product number P1305) until clear protein bands can be seen, and finally the purified G4 is obtained. The nanobody was analyzed by Image J software, and its purity was 95%. Figure 2 shows the expression and purification results of the specific anti-CTLA-4 nanobody.
实施例5抗CTLA-4纳米抗体与抗原的结合检测Example 5 Binding detection of anti-CTLA-4 nanobody and antigen
通过下面的步骤对实施例4获得的抗CTLA-4纳米抗体进行如下检测:The anti-CTLA-4 nanobody obtained in Example 4 was detected as follows through the following steps:
(1)将CTLA-4、PD-1(购于义翘神州,货号为10377-H02H)、PD-L1(购于义翘神州,货号为10084-HNAH)、CD28(购于义翘神州,货号为11524-HCCH)、CD80(购于义翘神州,货号为10698-HCCH)稀释为1μg/mL溶液,加入酶标板中,100ng/孔,4℃孵育过夜。同时设置对照。(1) CTLA-4, PD-1 (purchased in Yiqiao Shenzhou, item number 10377-H02H), PD-L1 (purchased in Yiqiao Shenzhou, item number 10084-HNAH), CD28 (purchased in Yiqiao Shenzhou, Product No. 11524-HCCH) and CD80 (purchased from Yiqiao Shenzhou, Product No. 10698-HCCH) were diluted to 1 μg/mL solution, added to the ELISA plate, 100 ng/well, and incubated at 4°C overnight. Also set controls.
(2)用300μL 0.1%PBST洗板,洗板一次,静置3min,每孔再加入300μL 5%脱脂奶粉,37℃封闭1h。(2) Wash the plate with 300 μL of 0.1% PBST, wash the plate once, let it stand for 3 minutes, add 300 μL of 5% nonfat milk powder to each well, and block at 37° C. for 1 hour.
(3)用300μL 0.1%PBST洗板,洗板一次,静置3min,将阳性对照anti-CTLA-4mAb(购于abcam,货号为ab237712)、空白对照PBS以及实验组实验组纳米抗体NbH3加入到酶标板,每孔100μL,100ng/孔,37℃孵育1h。(3) Wash the plate with 300 μL of 0.1% PBST, wash the plate once, and let it stand for 3 minutes. Add the positive control anti-CTLA-4mAb (purchased from abcam, the product number is ab237712), the blank control PBS and the experimental group nanobody NbH3 into the experimental group. ELISA plate, 100 μL per well, 100 ng/well, incubated at 37°C for 1 h.
(4)每孔加入300μL 0.1%PBST溶液洗板,洗板三次,每次静置3min,去掉未结合的抗体,再向每孔加入100μL 1:5000稀释的Mouse anti-HA mAb(购于proteintech,货号为66006-2-Ig),37℃孵育1h。(4) Add 300 μL of 0.1% PBST solution to each well to wash the plate, wash the plate three times, stand for 3 min each time, remove the unbound antibody, and then add 100 μL of 1:5000 diluted Mouse anti-HA mAb (purchased from proteintech) to each well. , Cat. No. 66006-2-Ig), incubated at 37°C for 1h.
(5)每孔加入300μL 0.1%PBST溶液洗板,洗板三次,每次静置3min,去掉未结合的抗体,再向每孔加入100μL 1:5000稀释的HRP-Goat Anti-Mouse IgG(H+L)(购于proteintech,货号为SA00001-1),37℃孵育1h。(5) Add 300 μL of 0.1% PBST solution to each well to wash the plate, wash the plate three times, stand for 3 min each time, remove the unbound antibody, and then add 100 μL of 1:5000 diluted HRP-Goat Anti-Mouse IgG (HRP-Goat Anti-Mouse IgG (H) to each well. +L) (purchased from proteintech, product number SA00001-1), incubated at 37°C for 1 h.
(6)每孔加入300μL 0.1%PBST溶液洗板,洗板五次,每次静置3min,每孔100μL的TMB溶液加入到酶标板中,37℃避光孵育10min。(6) Add 300 μL of 0.1% PBST solution to each well to wash the plate, wash the plate five times, stand for 3 minutes each time, add 100 μL of TMB solution per well to the ELISA plate, and incubate at 37°C for 10 minutes in the dark.
(7)再向酶标板中每孔加入100μL 2.29%硫酸终止反应,用酶标仪在450nm和630nm处测量OD值,计算OD450-OD630的差值即为所得的OD值。(7) Add 100 μL of 2.29% sulfuric acid to each well of the microtiter plate to stop the reaction, measure the OD value at 450nm and 630nm with a microplate reader, and calculate the difference between OD450-OD630 to obtain the OD value.
图3为抗CTLA-4纳米抗体与抗原的结合能力的分析结果,结果表明G4纳米抗体能特异性地与CTLA-4结合。FIG. 3 is the analysis result of the binding ability of the anti-CTLA-4 Nanobody to the antigen, and the result shows that the G4 Nanobody can specifically bind to CTLA-4.
实施例6抗CTLA-4纳米抗体热稳定性检测Example 6 Anti-CTLA-4 Nanobody Thermal Stability Detection
应用下述方法对所获得的抗CTLA-4纳米抗体的热稳定性进行检测:The thermal stability of the obtained anti-CTLA-4 Nanobodies was tested by the following method:
(1)用NaHCO3包被液稀释CTLA-4蛋白,以50ng/孔CTLA-4蛋白偶联在酶标板中,4℃过夜,并设置相应的阴性对照。(1) The CTLA-4 protein was diluted with NaHCO3 coating solution, 50ng/well CTLA-4 protein was coupled to the ELISA plate, overnight at 4°C, and the corresponding negative control was set.
(2)用300μL 0.1%PBST洗板,洗板一次,静置3min,每孔再加入300μL 5%脱脂奶粉,37℃封闭2h。(2) Wash the plate with 300 μL of 0.1% PBST, wash the plate once, let stand for 3 minutes, add 300 μL of 5% nonfat milk powder to each well, and block at 37° C. for 2 hours.
(3)将对照组为商购抗CTLA-4抗体(购自于百时美施贵宝Ipilimumab,货号为477202-00-9)和实验组G4纳米抗体(浓度均为500ng/mL)分别置于25℃、37℃、60℃、90℃下各0min、10min、30min、60min、120min以及180min。随后立即置于冰上。以100μL/孔加入到酶标板中,37℃孵育1h。(3) The control group was a commercial anti-CTLA-4 antibody (purchased from Bristol-Myers Squibb, Ipilimumab, product number 477202-00-9) and the experimental group G4 nanobody (both at a concentration of 500ng/mL) were placed in 25 0min, 10min, 30min, 60min, 120min and 180min at ℃, 37℃, 60℃, 90℃, respectively. Immediately thereafter place on ice. Add 100 μL/well to the ELISA plate and incubate at 37°C for 1 h.
(4)后续步骤与参照实施例5。(4) Subsequent steps and reference example 5.
图4为抗CTLA-4纳米抗体的热稳定性检测结果,实验结果表明G4纳米抗体的热稳定性具有良好的热稳定性。通常来说,一般的蛋白在60摄氏度会马上失去活性,即使在37摄氏度条件下也会很快失去活性,而G4纳米抗体在37摄氏度条件下相较于25摄氏度条件下,活性变化很小。在60摄氏度条件下虽然会丧失一部分活性,但是仍然保留60%以上的活性,结果表明G4纳米抗体具有良好的热稳定性。Figure 4 shows the thermal stability test results of the anti-CTLA-4 nanobody. The experimental results show that the thermal stability of the G4 nanobody has good thermal stability. Generally speaking, the general protein will lose its activity immediately at 60 degrees Celsius, even at 37 degrees Celsius, and the G4 nanobody will lose its activity very quickly at 37 degrees Celsius compared to 25 degrees Celsius. Although part of the activity will be lost at 60 degrees Celsius, more than 60% of the activity is still retained. The results show that the G4 nanobody has good thermal stability.
实施例7抗CTLA-4纳米抗体与人恶性黑色素瘤细胞A375细胞膜上CTLA-4分子结合Example 7 Binding of anti-CTLA-4 nanobodies to CTLA-4 molecules on human malignant melanoma cell A375 cell membrane
(1)取对数生长期的人恶性黑色素瘤细胞A375细胞(购于北京百欧博伟生物技术有限公司,货号为bio-72958),用0.25%胰蛋白酶(购于Gibco,货号为25200-072)消化,再用含有10%FBS(购于Gibco,货号为10270106)的DMEM培养基(购于Gibco,货号为C11995500BT)终止消化,得到单细胞悬液。1000rpm离心5min,弃上清后1×PBS清洗两遍。(1) Take human malignant melanoma cells A375 cells in logarithmic growth phase (purchased from Beijing Bio-Broadway Biotechnology Co., Ltd., product number: bio-72958), and use 0.25% trypsin (purchased from Gibco, product number: 25200-072) Digestion was then terminated with DMEM medium (purchased from Gibco, catalog number C11995500BT) containing 10% FBS (purchased from Gibco, catalog number 10270106) to obtain a single cell suspension. Centrifuge at 1000 rpm for 5 min, discard the supernatant and wash twice with 1×PBS.
(2)再用抗体稀释液稀释上述G4纳米抗体至50μg/mL,实验组每1×106个A375细胞分别加入100μL上述稀释的纳米抗体,阳性对照以1:100的比例稀释anti-CTLA-4mAb并加入到1×106个A375细胞中,同时设置阴性对照。37℃孵育1h。(2) Dilute the above G4 nanobody to 50 μg/mL with antibody diluent, add 100 μL of the above diluted nanobody to each 1×106 A375 cells in the experimental group, and dilute anti-CTLA- 4mAb was added to 1×106 A375 cells, and a negative control was set at the same time. Incubate for 1 h at 37°C.
(3)1000rpm离心5min,用1mL PBS溶液重悬,重复三次。实验组以1:100的比例稀释Mouse anti-His antibody(该抗体为所提供的G4纳米抗体连接上his标签),阳性对照组加入1:100的比例稀释的Mouse anti-CTLA-4mAb,以100μL上述抗体分别重悬细胞。37℃孵育45min。(3) Centrifuge at 1000 rpm for 5 min, resuspend with 1 mL of PBS solution, and repeat three times. The experimental group was diluted with Mouse anti-His antibody at a ratio of 1:100 (the antibody was attached with a his tag to the provided G4 nanobody), and the positive control group was added with Mouse anti-CTLA-4 mAb diluted at a ratio of 1:100, in 100 μL Cells were resuspended with the above antibodies. Incubate at 37°C for 45min.
(4)1000rpm离心5min,用1mL PBS溶液重悬,重复三次。以1:100的比例分别稀释流式抗体Goat anti-mouse IgG(FITC),每组加入100μL上述稀释的流式抗体,37℃避光30min。1000rpm离心5min,用1mL PBS溶液重悬,重复三次。最后用500μL的PBS的重悬。用流式细胞分析仪(购于BD,FACSCalibur)检测。结果用Flowjo 7.6.1分析。(4) Centrifuge at 1000 rpm for 5 min, resuspend with 1 mL of PBS solution, and repeat three times. The flow-through antibody Goat anti-mouse IgG (FITC) was diluted at a ratio of 1:100, 100 μL of the above-diluted flow-through antibody was added to each group, and the cells were protected from light at 37°C for 30 min. Centrifuge at 1000 rpm for 5 min and resuspend with 1 mL of PBS solution, repeating three times. Finally resuspend with 500 μL of PBS. Detected with flow cytometer (purchased from BD, FACSCalibur). Results were analyzed with Flowjo 7.6.1.
图5为抗CTLA-4纳米抗体与A375细胞膜上CTLA-4分子结合效率的结果图,结果表明,G4纳米抗体与A375细胞的CTLA-4具有强的特异性结合的能力。通过这种特异性结合,所提供的G4纳米抗体可以用来治疗CTLA-4过表达为特征的疾病。Figure 5 is a graph showing the results of the binding efficiency of the anti-CTLA-4 nanobody to CTLA-4 molecules on the A375 cell membrane. The results show that the G4 nanobody has a strong ability to specifically bind to CTLA-4 of A375 cells. Through this specific binding, the provided G4 Nanobodies can be used to treat diseases characterized by CTLA-4 overexpression.
此外,术语“第一”、“第二”仅用于描述目的,而不能理解为指示或暗示相对重要性或者隐含指明所指示的技术特征的数量。由此,限定有“第一”、“第二”的特征可以明示或者隐含地包括至少一个该特征。在本发明的描述中,“多个”的含义是至少两个,例如两个,三个等,除非另有明确具体的限定。In addition, the terms "first" and "second" are only used for descriptive purposes, and should not be construed as indicating or implying relative importance or implying the number of indicated technical features. Thus, a feature delimited with "first", "second" may expressly or implicitly include at least one of that feature. In the description of the present invention, "plurality" means at least two, such as two, three, etc., unless otherwise expressly and specifically defined.
在本说明书的描述中,参考术语“一个实施例”、“一些实施例”、“示例”、“具体示例”、或“一些示例”等的描述意指结合该实施例或示例描述的具体特征、结构、材料或者特点包含于本发明的至少一个实施例或示例中。在本说明书中,对上述术语的示意性表述不必针对的是相同的实施例或示例。而且,描述的具体特征、结构、材料或者特点可以在任一个或多个实施例或示例中以合适的方式结合。此外,在不相互矛盾的情况下,本领域的技术人员可以将本说明书中描述的不同实施例或示例以及不同实施例或示例的特征进行结合和组合。In the description of this specification, description with reference to the terms "one embodiment," "some embodiments," "example," "specific example," or "some examples", etc., mean specific features described in connection with the embodiment or example , structure, material or feature is included in at least one embodiment or example of the present invention. In this specification, schematic representations of the above terms are not necessarily directed to the same embodiment or example. Furthermore, the particular features, structures, materials or characteristics described may be combined in any suitable manner in any one or more embodiments or examples. Furthermore, those skilled in the art may combine and combine the different embodiments or examples described in this specification, as well as the features of the different embodiments or examples, without conflicting each other.
尽管上面已经示出和描述了本发明的实施例,可以理解的是,上述实施例是示例性的,不能理解为对本发明的限制,本领域的普通技术人员在本发明的范围内可以对上述实施例进行变化、修改、替换和变型。Although the embodiments of the present invention have been shown and described above, it should be understood that the above-mentioned embodiments are exemplary and should not be construed as limiting the present invention. Embodiments are subject to variations, modifications, substitutions and variations.
SEQUENCE LISTINGSEQUENCE LISTING
<110> 佛山汉腾生物科技有限公司,暨南大学<110> Foshan Hanteng Biotechnology Co., Ltd., Jinan University
<120> 抗CTLA-4纳米抗体及其在肿瘤治疗中的应用<120> Anti-CTLA-4 Nanobody and Its Application in Tumor Therapy
<130> PIDC3200190<130> PIDC3200190
<160> 5<160> 5
<170> PatentIn version 3.5<170> PatentIn version 3.5
<210> 1<210> 1
<211> 161<211> 161
<212> PRT<212> PRT
<213> Artificial Sequence<213> Artificial Sequence
<220><220>
<223> 抗CTLA-4纳米抗体<223> Anti-CTLA-4 Nanobody
<400> 1<400> 1
Met Lys Tyr Leu Leu Pro Thr Ala Ala Ala Gly Leu Leu Leu Leu AlaMet Lys Tyr Leu Leu Pro Thr Ala Ala Ala Gly Leu Leu Leu Leu Ala
1 5 10 151 5 10 15
Ala Gln Pro Ala Met Ala Gln Val Gln Leu Gln Glu Ser Gly Gly GlyAla Gln Pro Ala Met Ala Gln Val Gln Leu Gln Glu Ser Gly Gly Gly
20 25 30 20 25 30
Ser Val Gln Ala Gly Gly Ser Leu Arg Leu Ser Cys Ala Ala Ser GlySer Val Gln Ala Gly Gly Ser Leu Arg Leu Ser Cys Ala Ala Ser Gly
35 40 45 35 40 45
Tyr Arg Tyr Ser Pro Tyr Cys Met Ser Trp Phe Arg Gln Ser Pro GlyTyr Arg Tyr Ser Pro Tyr Cys Met Ser Trp Phe Arg Gln Ser Pro Gly
50 55 60 50 55 60
Lys Ala Arg Glu Gly Val Ala Asn Ile Asp Ser Asp Gly Ser Thr SerLys Ala Arg Glu Gly Val Ala Asn Ile Asp Ser Asp Gly Ser Thr Ser
65 70 75 8065 70 75 80
Tyr Ala Asp Ser Val Lys Gly Arg Phe Thr Ile Ser Lys Asp Asn AlaTyr Ala Asp Ser Val Lys Gly Arg Phe Thr Ile Ser Lys Asp Asn Ala
85 90 95 85 90 95
Lys Asn Thr Leu Tyr Leu Gln Met Asn Ser Leu Lys Ala Glu Asp ThrLys Asn Thr Leu Tyr Leu Gln Met Asn Ser Leu Lys Ala Glu Asp Thr
100 105 110 100 105 110
Ala Met Tyr Tyr Cys Ala Ala Asp Pro Ala Ser Phe Gly Asp Cys TyrAla Met Tyr Tyr Cys Ala Ala Asp Pro Ala Ser Phe Gly Asp Cys Tyr
115 120 125 115 120 125
Ser Gly Ser Trp Ser Pro Glu Thr Ile Trp Gly Gln Gly Thr Gln ValSer Gly Ser Trp Ser Pro Glu Thr Ile Trp Gly Gln Gly Thr Gln Val
130 135 140 130 135 140
Thr Val Ser Ser Ala Ala Ala Tyr Pro Tyr Asp Val Pro Asp Tyr GlyThr Val Ser Ser Ala Ala Ala Tyr Pro Tyr Asp Val Pro Asp Tyr Gly
145 150 155 160145 150 155 160
SerSer
<210> 2<210> 2
<211> 486<211> 486
<212> DNA<212> DNA
<213> Artificial Sequence<213> Artificial Sequence
<220><220>
<223> 编码抗CTLA-4纳米抗体的核酸序列<223> Nucleic acid sequence encoding anti-CTLA-4 Nanobody
<400> 2<400> 2
atgaaatacc tattgcctac ggcagccgct ggattgttat tactcgcggc ccagccggcc 60atgaaatacc tattgcctac ggcagccgct ggattgttat tactcgcggc ccagccggcc 60
atggcccagg tgcagctgca ggagtctgga ggaggctcgg tgcaggctgg agggtctctg 120atggcccagg tgcagctgca ggagtctgga ggaggctcgg tgcaggctgg agggtctctg 120
agactctcct gtgcagcctc tggatatcga tatagtcctt actgcatgag ctggttccga 180agactctcct gtgcagcctc tggatatcga tatagtcctt actgcatgag ctggttccga 180
caaagcccag ggaaagctcg cgaaggtgtt gctaatatcg acagcgatgg tagtacttcc 240caaagcccag ggaaagctcg cgaaggtgtt gctaatatcg acagcgatgg tagtacttcc 240
tatgctgata gtgtaaaagg tcgatttact attagcaaag ataatgcaaa gaacactcta 300tatgctgata gtgtaaaagg tcgatttact attagcaaag ataatgcaaa gaacactcta 300
tatttacaaa tgaattcatt aaaagccgaa gatacagcta tgtattactg tgctgccgat 360tatttacaaa tgaattcatt aaaagccgaa gatacagcta tgtattactg tgctgccgat 360
cccgcctcct ttggtgattg ctactcgggg tcctggtccc cggaaacaat atggggccag 420cccgcctcct ttggtgattg ctactcgggg tcctggtccc cggaaacaat atggggccag 420
gggacccagg tcaccgtctc ctcagcggcc gcatacccgt acgacgttcc ggactacggt 480gggacccagg tcaccgtctc ctcagcggcc gcatacccgt acgacgttcc ggactacggt 480
tcctaa 486tcctaa 486
<210> 3<210> 3
<211> 53<211> 53
<212> DNA<212> DNA
<213> Artificial Sequence<213> Artificial Sequence
<220><220>
<223> F-primer<223> F-primer
<400> 3<400> 3
gaggaggagg aggaggtggc ccaggcggcc caggtsmarc tgcagsagtc wgg 53gaggaggagg aggaggtggc ccaggcggcc caggtsmarc tgcagsagtc wgg 53
<210> 4<210> 4
<211> 56<211> 56
<212> DNA<212> DNA
<213> Artificial Sequence<213> Artificial Sequence
<220><220>
<223> R-primer 1<223> R-
<400> 4<400> 4
gaggaggagg aggaggtggc ccaggcggcc ggagctgggg tcttcgctgt ggtgcg 56gaggaggagg aggaggtggc ccaggcggcc ggagctgggg tcttcgctgt ggtgcg 56
<210> 5<210> 5
<211> 56<211> 56
<212> DNA<212> DNA
<213> Artificial Sequence<213> Artificial Sequence
<220><220>
<223> R-primer 2<223> R-primer 2
<400> 5<400> 5
gaggaggagg aggaggtggc ccaggcggcc tggttgtggt tttggtgtct tgggtt 56gaggaggagg aggaggtggc ccaggcggcc tggttgtggt tttggtgtct tgggtt 56
Claims (14)
Translated fromChinesePriority Applications (1)
| Application Number | Priority Date | Filing Date | Title |
|---|---|---|---|
| CN202010048826.0ACN111153997B (en) | 2020-01-16 | 2020-01-16 | Anti-CTLA-4 Nanobody and Its Application in Tumor Therapy |
Applications Claiming Priority (1)
| Application Number | Priority Date | Filing Date | Title |
|---|---|---|---|
| CN202010048826.0ACN111153997B (en) | 2020-01-16 | 2020-01-16 | Anti-CTLA-4 Nanobody and Its Application in Tumor Therapy |
Publications (2)
| Publication Number | Publication Date |
|---|---|
| CN111153997A CN111153997A (en) | 2020-05-15 |
| CN111153997Btrue CN111153997B (en) | 2022-06-24 |
Family
ID=70563574
Family Applications (1)
| Application Number | Title | Priority Date | Filing Date |
|---|---|---|---|
| CN202010048826.0AActiveCN111153997B (en) | 2020-01-16 | 2020-01-16 | Anti-CTLA-4 Nanobody and Its Application in Tumor Therapy |
Country Status (1)
| Country | Link |
|---|---|
| CN (1) | CN111153997B (en) |
Families Citing this family (1)
| Publication number | Priority date | Publication date | Assignee | Title |
|---|---|---|---|---|
| CN114702575B (en)* | 2022-01-24 | 2023-05-23 | 广东医科大学 | Anti-SARS-CoV-2 S protein nanobody, recombinant nanobody, recombinant vector, recombinant bacteria and application |
Citations (4)
| Publication number | Priority date | Publication date | Assignee | Title |
|---|---|---|---|---|
| EP3004170A1 (en)* | 2013-05-28 | 2016-04-13 | VIB vzw | Single domain antibodies against sod1 and their use in medicine |
| CN106220732A (en)* | 2015-07-20 | 2016-12-14 | 广西医科大学 | Nano antibody Nb16 of anti-CTLA 4 and preparation method and application |
| CN108299561A (en)* | 2018-01-02 | 2018-07-20 | 暨南大学 | A kind of PD-1 nano antibodies and its cloning expression method and application |
| CN110256563A (en)* | 2019-07-05 | 2019-09-20 | 石河子大学 | CTLA-4 nano antibody, preparation method and applications |
- 2020
- 2020-01-16CNCN202010048826.0Apatent/CN111153997B/enactiveActive
Patent Citations (4)
| Publication number | Priority date | Publication date | Assignee | Title |
|---|---|---|---|---|
| EP3004170A1 (en)* | 2013-05-28 | 2016-04-13 | VIB vzw | Single domain antibodies against sod1 and their use in medicine |
| CN106220732A (en)* | 2015-07-20 | 2016-12-14 | 广西医科大学 | Nano antibody Nb16 of anti-CTLA 4 and preparation method and application |
| CN108299561A (en)* | 2018-01-02 | 2018-07-20 | 暨南大学 | A kind of PD-1 nano antibodies and its cloning expression method and application |
| CN110256563A (en)* | 2019-07-05 | 2019-09-20 | 石河子大学 | CTLA-4 nano antibody, preparation method and applications |
Non-Patent Citations (4)
| Title |
|---|
| A nanobody against CTLA-4 increases the anti-tumor effects of specific CD8+ T cells;Mo F. 等;《第十七届国际免疫学大会会议论文集》;20191031;第1809页* |
| immunoglobulin heavy chain, partial [Lama glama];Nguyen,V.K. 等;《Genbank Database》;20160726;ACCESSION NO. CAD13187* |
| 免疫检查点抑制剂在肿瘤治疗中的应用;艾斌;《医学与哲学:临床决策论坛版》;20150228;第36卷(第2B期);第18-21页* |
| 重组人CTLA-4胞外段的表达纯化及其纳米抗体的筛选与功能鉴定;吴利文;《中国优秀硕士学位论文全文数据库 医药卫生科技辑》;20210215(第2期);E059-234* |
Also Published As
| Publication number | Publication date |
|---|---|
| CN111153997A (en) | 2020-05-15 |
Similar Documents
| Publication | Publication Date | Title |
|---|---|---|
| CN109096396B (en) | anti-PD-L1 humanized nano antibody and application thereof | |
| CN107216389B (en) | anti-PD-L1 nano antibody and coding sequence and application thereof | |
| US9574012B2 (en) | AGR2 blocking antibody and use thereof | |
| CN108299561B (en) | A PD-1 nanobody and its cloning and expression method and application | |
| CN116082523B (en) | A chimeric antigen receptor targeting Claudin18.2 and its application | |
| CN116003598B (en) | Recombinant humanized monoclonal antibody targeting human GPRC5D and application thereof | |
| WO2018195226A1 (en) | Anti-pd-l1 antibody and use thereof | |
| CN110144011B (en) | Single domain antibodies against T lymphocyte immunoglobulin mucin3 | |
| CN113004415B (en) | Bispecific antibody targeting HER2 and 4-1BB and application thereof | |
| CN104098698A (en) | Antibody against CD3, and preparation method and application thereof | |
| AU2021342525A1 (en) | Single-domain antibody targeting 4-1bb, fusion protein thereof, pharmaceutical composition and use thereof | |
| CN111171151B (en) | anti-EGFR (epidermal growth factor receptor) nano antibody and application thereof | |
| CN111234019B (en) | anti-CTLA-4 nano antibody, pharmaceutical composition and application thereof | |
| CN116874599A (en) | Chimeric antigen receptor T cell targeting human DLL3 and application thereof | |
| CN110885377B (en) | anti-CD 47/VEGF bispecific antibody and application thereof | |
| CN111153997B (en) | Anti-CTLA-4 Nanobody and Its Application in Tumor Therapy | |
| CN111153998B (en) | anti-CTLA-4 nano antibody and application thereof | |
| WO2024078288A1 (en) | Anti-rcp antibody and preparation method therefor | |
| CN111333732B (en) | Preparation and application of a bispecific antibody targeting human BCMA and activating NK cells | |
| CN113754770A (en) | Antibody specifically binding to human CTLA4, and medicine and kit containing antibody | |
| JP2018508206A (en) | Antibodies against L-type voltage-gated channels and related methods | |
| CN118754987B (en) | A tight junction protein antibody H04 and its application | |
| CN118754988B (en) | Tight junction protein antibody G4 and application thereof | |
| CN119320451B (en) | Tight junction protein antibody D03 and application thereof | |
| CN117915950A (en) | Multispecific antibody and application thereof |
Legal Events
| Date | Code | Title | Description |
|---|---|---|---|
| PB01 | Publication | ||
| PB01 | Publication | ||
| SE01 | Entry into force of request for substantive examination | ||
| SE01 | Entry into force of request for substantive examination | ||
| GR01 | Patent grant | ||
| GR01 | Patent grant |